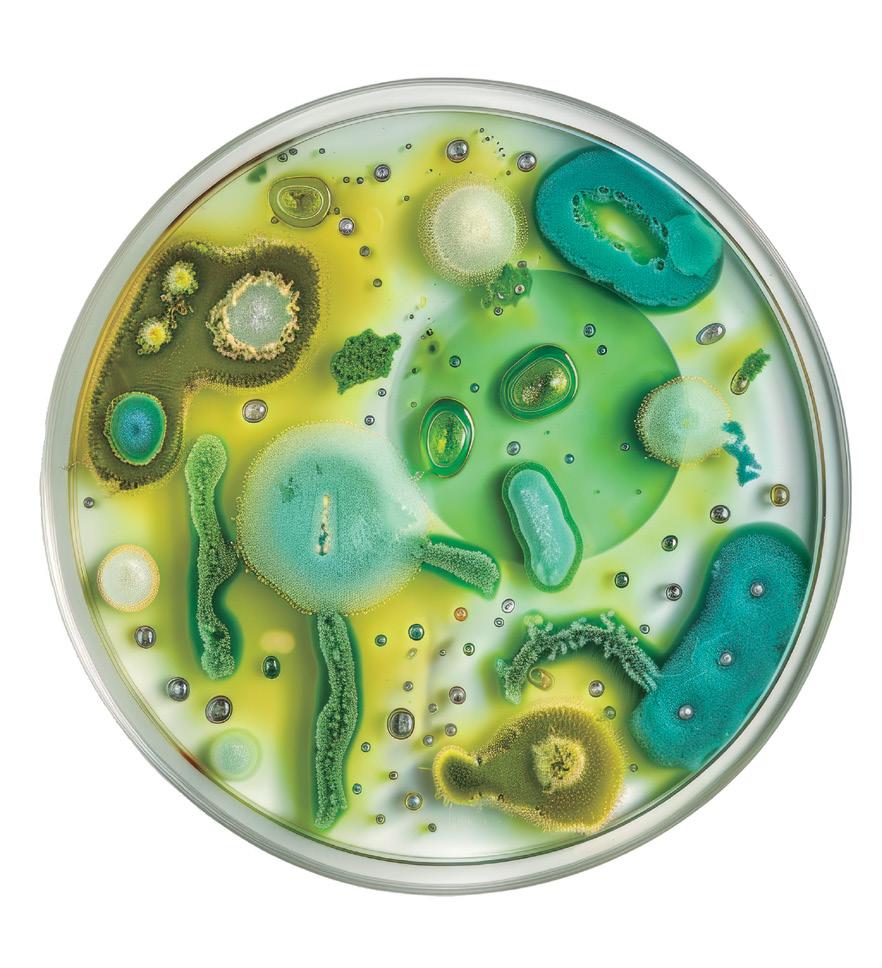

SEMANARIO
No. 418 • Año 9 • Del 30 de septiembre al 4 de octubre 2024

![]()
No. 418 • Año 9 • Del 30 de septiembre al 4 de octubre 2024

Pág. 6

MORENA TENDRÁ PRESUPUESTO MILLONARIO
Sin elecciones a la vista, para 2025 el partido guinda recibirá más de dos mil millones de pesos Pág. 14

Hoy escriben
Aislamiento y quiebre. Pág. 16
Sheinbaum viene acompañada de grandes expectativas. Eso es normal en todo cambio de gobierno, pero en México y en los tiempos actuales, hay mucho más de fondo. Una de las más importantes expectativas que despierta el relevo, quizá la de más peso, se observa en el recurrente comentario sobre la oportunidad de superar la división sembrada y que, durante seis años, ha consumido mucha de la energía de México y de los mexicanos. El mensaje de la presidenta, pedir licencia a su militancia partidista en Morena porque ahora debe gobernar para todos, no solo para los suyos, es justo la señal de arranque que se necesitaba, pronunciada además en el foro adecuado, ante sus correligionarios morenistas.
La ganadora se lleva… casi todo
El presupuesto asignado no es la única, pero sin duda también es una forma de medir la influencia, el avance y por lo tanto, las victorias y las derrotas en política. Luisa María Alcalde, la nueva presidenta nacional de Morena, administrará un histórico –por lo abultado–, presupuesto de más de 2.3 mil millones de pesos para 2025, proveniente de la prerrogativa del partido en el gobierno, definida en función de los votos conquistados en la elección de diputados federales de 2024. Los recursos son menores a los 3.1 mil millones que Mario Delgado y Citlalli Hernández administraron para 2024, pero el detalle está en que 2025 no tiene ni elecciones federales, ni tampoco elecciones de gobernadores en el calendario, mientras que en 2024 se celebró la madre de todas las elecciones con la renovación de la Presidencia, las cámaras de diputados federales y senadores, así como de varias gubernaturas. Si se consideran los mil millones de pesos de presupuesto que se estima asignar a la nueva Secretaría de las Mujeres para 2025, y se les compara con los recursos de
Morena, se puede también dimensionar el tamaño de la victoria de Alcalde sobre Citlalli Hernández.
Bastión azul
En Guanajuato también hay cambio y, como a nivel federal, una mujer gobierna por primera vez en el espacio del panismo por excelencia. Libia Dennise García Muñoz Ledo armó un buen gabinete con Juan Mauro González Martínez en Seguridad y Paz, Lizeth Galván Cortés en la Secretaría de Cultura, Héctor Salgado Banda en Finanzas y Daniel Jiménez Lona en la Secretaría de Gobierno. La gobernadora Denisse García tiene, con ese grupo y en esa entidad federativa, todo para convertirse en uno de los factores de unidad y liderazgo dentro de su partido, pero también en un referente para toda la oposición, hacia el futuro inmediato.
Juicios nulos, otro riesgo
Decían las abuelas que las cosas hechas con prisas, normalmente salen mal, y tenían razón. Cada día que pasa le aparecen nuevos
Director General Rodrigo Jiménez Sólomon
Director Editorial Alejandro Envila Fisher
Coordinador de diseño
Juan Luis Gutiérrez
Editora
Bet-biraí Nieto
Editora web
Norma Montiel
Director de Relaciones Institucionales Alfredo Gutiérrez
Contenidos y edición web
Marco Aguilar, Brenda Mireles, Jonathan Nácar, Tania Rosas, Manuel Lino, Gustavo Cano, Diego Jiménez, Leonardo Ramírez y Ángel Magno Roldán
Diseño e ilustración
Amaranta Ruiz, Kevin Gutiérrez, y Gilberto Bobadilla.
Retoque Paola Salas

EL PODERÍO del huracán John dejó 13 muertos en Guerrero, así como cientos de desplazados. Entre los fallecidos se encuentran cuatro niños, y tres trabajadores de una minera. El fenómeno provocó inundaciones severas en Acapulco, así como deslizamientos de tierra y carreteras devastadas. Los deslaves dejaron daños materiales en vehículos particulares, que resultaron aplastados por rocas, y un hotel reportó el colapso de parte de su estructura
defectos a la Reforma Judicial que ya es ley porque está en la Constitución. Algún curioso se puso a desempolvar criterios jurisprudenciales de la Corte y a analizar las teorías y doctrinas legales vigentes para encontrarse con algo muy delicado que se llama principio de inmutabilidad. Se trata de una garantía procesal de las partes que obliga a que el mismo juez que admitió una demanda, conoció a las partes en conflicto y valoró sus pruebas, sea quien dicte la sentencia correspondiente porque es quién conoce de verdad la disputa. Con la reforma judicial y la fecha límite para que el 1 de septiembre próximo, al menos la mitad de los jueces y magistrados federales cesen en sus funciones y dejen su lugar a los que resulten electos el 1 de junio, esa garantía procesal no se cumpliría y todos los juicios no concluidos al llegar el nuevo juez, podrían ser declarados nulos si el perdedor se inconforma. Hay quien habla
de medio millón de litigios en riesgo, pero en realidad podrían ser muchos más porque esa cifra no considera el llamado rezago judicial, derivado de que el país no tiene suficientes jueces ni juzgados.
Fortaleza institucional
También en Morena habrá manifestaciones, y muy importantes, en los siguientes días. Uno a uno, los 22 gobernadores del partido mayoritario y la Jefa de Gobierno de la CDMX, tendrán su oportunidad de ir mostrando y refrendando su lealtad a la nueva lideresa del movimiento, que aunque haya pedido licencia a su militancia, es la cabeza del partido en el gobierno, como ocurre en cualquier sistema político. No faltará el despistado que crea que puede obtener ventajas de regatear su apoyo, pero la institucionalidad acabará imponiéndose.

Directora de Planeación Ivonne Cid
Consejo Editorial Julieta Mendoza, Sergio Uzeta, Enrique Lazcano y Pablo Reinah.
El semanario ejecentral es publicado por OFEM Media Group OMG, S.A. de C.V.; Av. Santa Fe 443, Piso 35, Cuajimalpa de Morelos, C.P. 05000, Ciudad de México. Teléfono: 55 5662-1453, correo: ejecentralredaccion@ gmail.com Permisos: Número de Certificado de Reserva otorgado por el Instituto Nacional del Derecho de Autor: 04-2019-101414030900-101. Número de Certificado de Licitud de Título y Contenido: 17374. Editor responsable: Adrián Castillo. Impreso en Impresora de Periódicos Diarios, S. de R.L. de C.V., con domicilio en Acalotenco 80, colonia Santo Tomás, delegación Azcapotzalco, Ciudad de México, Código Postal 02020, Teléfono 555352 0999. El contenido de los artículos es responsabilidad exclusiva de los autores. Todos los derechos están reservados. Queda prohibida la reproducción parcial o total del material publicado.







: EN 2023, los actos terroristas a nivel mundial aumentaron en letalidad pese a la disminución de ataques, con el Sahel, como epicentro emergente, y Burkina Faso entre los pa íses más afectados
BET-BIRAÍ NIETO MORALES bnieto@ejecentral.com.mx
En 2023, la actividad terrorista aumentó de manera alarmante, con ataques más letales a pesar de una reducción en su número total. Estas acciones, realizadas por grupos no estatales o individuos, pueden variar en su escala, desde atentados menores hasta eventos masivos como el 11 de septiembre en Nueva York en 2001 o la incursión en territorio israelí y el secuestro de ciudadanos por parte de Hamás el año pasado.
La actividad terrorista global mostró un aumento en la letalidad con 22% en muertes, pese a una reducción de, también, 22% en los ataques. Esto indica que, aunque hubo menos atentados, los ocurridos fueron más mortales, lo que refleja la evolución de tácticas terroristas más destructivas y mejor planificadas, según los resultados del más reciente Índice Global del Terrorismo (GTI, por sus siglas en inglés).
El ataque más mortífero del año fue perpetrado por Hamás en Israel, el 7 de octubre, que causó mil 200 muertes. La respuesta militar de Israel derivó en el deceso de 25 mil palestinos hasta febrero de 2024.
En 2023, Irak registró menos de 100 muertes relacionadas con ataques terroristas, una disminución de 99% respecto al máximo alcanzado en 2007. Así, Afganistán logró una caída de 84% en el número de muertes y de 75% en los incidentes terroristas en comparación con su peor momento en 2007.
El Índice señala que los grupos más mortíferos fueron el Estado Islámico (EI) y sus afiliados, seguido de Jamaat Nusrat Al-Islam wal Muslimeen (JNIM), Hamás y al-Shabaab.
El Estado Islámico, que es el grupo más letal a nivel mundial por noveno año consecutivo, de acuerdo con el análisis del GTI, registró el mayor número de agresiones como de decesos derivados de los , aunque su impacto ha disminuido de manera constante desde su pico en 2014.
Cabe mencionar que el informe internacional no incluyó los actos cometidos por los talibanes, ya que, desde que este grupo asumió el poder en Afganistán, sus acciones no son consideradas dentro del alcance del estudio.
PUNTAJE CERO
PUNTAJE POR PAÍS
¿Qué es el terrorismo?
El terrorismo se define como el uso intencionado de la violencia o amenazas contra civiles para causar miedo, coaccionar gobiernos y alcanzar fines políticos, religiosos o ideológicos. Según organismos como la ONU, estas acciones buscan desestabilizar estructuras políticas y económicas
EL GTI indica que, a pesar de la reducción de grupos terroristas activos de 141 en 2009 a 66 en 2023, la letalidad de los ataques va en aumento.
MalasiaIslandia|0.233 Esuatini|0.192 Ecuador|0.18 Bahrain|0.167 Rwanda|0.123 Uruguay|0.114 |0.114IrlandaLituania|0.059 |0.03
3,350 INCIDENTES terroristas fueron registrados durante 2023 a nivel mundial.

Foto:
ALFONSO CEPEDA subrayó la importancia de construir un México más justo y democrático..
La iniciativa busca fomentar valores fundamentales como el respeto, la igualdad, la solidaridad, la tolerancia y la empatía en los entornos educativos
Redacción-Eje-Content
El Sindicato Nacional de Trabajadores de la Educación (SNTE) inició a la campaña ¡Ármate de valor por una Cultura de Paz! Infórmate, Conoce y Actúa. Esta iniciativa busca fomentar valores fundamentales como el respeto, la igualdad, la solidaridad, la tolerancia y la empatía en los entornos educativos. Durante el lanzamiento de la campaña, el secretario general del SNTE, Alfonso Cepeda Salas, hizo un llamado a todos los docentes y miembros de la comunidad educativa para que se sumen a esta causa. “Es esencial que nuestros planteles sean ejemplos de convivencia armónica. Instamos a colocar una bandera blanca en las más de 250 mil escuelas públicas del país, simbolizando nuestro compromiso con la paz”, afirmó Cepeda. El líder sindical subrayó la importancia de construir un México más justo y democrático, resaltando que el SNTE continuará desempeñando un papel crucial en este proceso transformador. “Refrendamos nuestra determinación de ser actores activos en la construcción de un país libre, soberano y desarrollado, pilares de la transformación que todos anhelamos”, agregó.
La ceremonia de inicio también contó con la participación de Rosa Icela Rodríguez Velázquez, secretaria de Seguridad y Protección Ciudadana, quien destacó el compromiso de los educadores en promover una Cultura de Paz. Rodríguez Velázquez invitó a los trabajadores de la educación a seguir contribuyendo para que las escuelas se mantengan como espacios seguros. “La campaña que lanzan hoy es prueba de su sentido de responsabilidad. Contribuye a uno de los objetivos del gobierno del presidente Andrés Manuel López Obrador, que es la construcción de la paz en todos los espacios”, dijo.
La secretaria enfatizó que esta política de paz será una prioridad en el gobierno de Claudia Sheinbaum Pardo, quien manifestó la importancia de abordar las raíces de la violencia para brindar tranquilidad a las familias.El evento fue presenciado por diversas figuras políticas, incluidos los senadores Jesús Lucía Trasviña Waldenrath, Enrique Inzunza Cázarez y Manuel Huerta Ladrón de Guevara.
Asimismo, los secretarios generales de las secciones 9, 10, 11, 60 y 61 del SNTE, junto con miembros de los Órganos Nacionales de Gobierno sindical, asistieron al lanzamiento, que fue seguido en línea por más de 100 mil agremiados en todo el país.

MELISSA GALVÁN mgalvan@la-lista.com
Keren Selsy Ordoñez se estaba recuperando de una cesárea y cargaba a su bebé recién nacida cuando elementos de la Policía de Tlaxcala y Federal la detuvieron a unas calles de su casa en Xalapa, Veracruz. La joven había salido a buscar al padre de su hija para pedirle manutención y terminó acusada de secuestro. Era diciembre de 2015 y Keren tenía 19 años. En esa condición se enfrentó a amenazas, golpes y tortura, lo que la llevó a firmar una declaración de culpabilidad que la condenó a 50 años de prisión.
A simple vista, podría pensarse que el caso de Keren fue fortuito y que “estuvo en el lugar y momento equivocados”, pero en realidad es víctima de un sistema de justicia que la criminalizó con un claro sesgo de género, señala Melissa Zamora, abogada del Centro de Derechos Humanos Miguel Agustín Pro Juárez (Centro ProDH) y representante legal de la joven.
Ciria Hernández, mamá de Keren, considera que el único error de su hija fue haberse enamorado del “hombre equivocado”, quien la abandonó cuando supo que estaba embarazada y reapareció “solo para vincularla” a un delito.
Keren era una joven apegada a su madre, que soñaba con terminar la preparatoria y empezar sus estudios universitarios para brindarles una mejor vida a sus padres. Sin embargo, conoció al padre de su hija, cuya actividad ilícita la alejaría de su familia.
Todo el embarazo de Keren fue de alto riesgo debido a la preeclampsia. El primer mes de su maternidad transcurrió con normalidad hasta que, el 11 de diciembre de 2015, su expareja la atrajo a su casa bajo el argumento de que le daría dinero para la manutención de la bebé.
Mientras esperaba afuera de la casa de su expareja, con su bebé en brazos, personas armadas descendieron de vehículos oficiales y, sin mediar palabra, sometieron a Keren y a su hija. Dentro del domicilio, detuvieron también a su expareja y a otra persona, y liberaron a una mujer que estaba secuestrada. “No hubo ninguna orden de aprehensión
Y AMENAZAS, Keren Ordoñez fue obligada a declararse culpable de un delito que no cometió. Hoy tiene la posibilidad de ser absuelta y liberada

Keren fue víctima de una detención arbitraria en Xalapa, Veracruz, y actualmente está recluida en Tlaxcala.

en la que se le informara a Keren por qué estaba siendo detenida; por el contrario, le arrancaron a la bebé de sus brazos y la sometieron desde el primer momento a distintos tipos de violencia, como tortura física y psicológica, pues la amenazaron con hacerle daño a su bebé si no reconocía que había participado en el secuestro”, puntualiza la abogada Melissa Zamora.
Ella sentenciada, él libre
En 2019, un juzgado penal en Apizaco, Tlaxcala, dictó sentencias condenatorias para Keren, su expareja y el sujeto detenido en el domicilio.
prisión para Keren, contra quien no había pruebas ni testimonios, mientras que el papá de su hija fue condenado a cinco años de cárcel, de los cuales solo cumplió cuatro.
La expareja de la joven tenía 17 años al momento de cometer el secuestro y fue juzgado bajo el sistema penal para adolescentes.
En 2021, la defensa legal de Keren impugnó la sentencia y un tribunal colegiado concedió el amparo al considerar que se habían violentado los derechos procesales de la joven; además, ordenó reponer el proceso. Keren está a un paso de ser absuelta y liberada, aunque la Fiscalía de Tlaxcala pida lo contrario.

EL TEXTO COMPLETO y más detalles en La-Lista.

El juez impuso 50 años de
Escanea este código para entrar.
El caso de Keren ejemplifica cómo las mujeres jóvenes, en situaciones de vulnerabilidad, pueden verse atrapadas en la red de un sistema judicial que las penaliza de manera desproporcionada. Su historia pone en evidencia la necesidad urgente de revisar los procesos judiciales y asegurar que las detenciones no sean arbitrarias ni violentas, especialmente cuando se trata de mujeres que han sido víctimas de violencia física y emocional.

1.Sin duda, la Presidenta Claudia Sheinbaum iniciará su gobierno con gran aceptación nacional. También asumirá el poder en un entorno complejo, diferente al que pudiera esperarse de una transición tranquila, pues el país se encuentra con desafíos de seguridad, economía y confianza, que representan oportunidades para actuar, pero también riesgos si las soluciones se plantean sin inclusión y el más amplio consenso posible. El país le da la bienvenida a una nueva etapa de continuidad con cambio en la que, como ha señalado, podrá gobernar para todos haciendo de los riesgos, oportunidades de desarrollo y prosperidad.
unilateralmente los términos del TMEC con reformas como la judicial y la eventual desaparición de los órganos autónomos, afectando los acuerdos compartidos.
Pentagrama es un espacio de opinión y estudio de la realidad en el que se analizan, con enfoque prospectivo, los hechos de la política y del acontecer legislativo.
2.La economía ha entrado en una pausa y se desacelera, con una probabilidad de crecimiento para el año rondando el 1%, en tanto que para el 2025 se estima aún menor, quizá de 0.8 por ciento. Los agentes económicos hablan de una posible recesión técnica, mientras en Estados Unidos, habiendo iniciado el ciclo de reducción de tasas, se confía en que la FED podrá conducir un aterrizaje suave e impulsar el crecimiento hasta 2 por ciento. ¿Por qué México desaprovecharía ese impulso? Esencialmente, por la incertidumbre y desconfianza del cambio de reglas. Como dirían en el Departamento de Estado, nuestro país ha comenzado a renegociar
3.De ahí que numerosas inversiones y proyectos se han pausado hasta en tanto las agencias calificadoras reevalúen el riesgo país y el grado de inversión, arriesgando una degradación que afectaría a los mercados. Algunas corredurías como Morgan Stanley y JP Morgan recomiendan negativamente a sus clientes sobre invertir en México y les sugieren esperar o irse a mercados más seguros como India o Brasil. Hasta Texas está pescando en río revuelto y ofrece a inversionistas las facilidades fiscales y financieras si se reubican en una especie de zona especial, donde el gobernador Greg Abbott les garantiza seguridad, certidumbre jurídica y energía eléctrica y gas abundante y barato. Con ello, Texas busca disputar a México el ser la tierra prometida del nearshoring. En cuanto a seguridad, se vive una situación muy crítica en varias entidades, sobre todo en Sinaloa y Chiapas, en donde el enfrentamiento entre las facciones del cártel del Pacífico, los mayos y Los Chapitos, han desbordado todas las previsiones.
4.Como en todo cambio de gobierno, puede haber nuevas ideas y estilo personal de gobernar. Habrá algunos casos que prosigan la
ruta trazada, como son las reformas legislativas por venir, pero hay espacio para que las formas y las maneras cambien para tornar a la política en instrumento de estabilidad, reconciliación y cauce de los conflictos.
5.No porque la oposición esté tumbada significa que los demás factores reales de poder lo estén también. Al menos 40% de los electores no votaron por la coalición gobernante, beneficiada por la sobrerrepresentación. Y tanto Estados Unidos, como los empresarios, la Iglesia y hasta los narcos habrán de esperar un new deal que reduzca los costos y las apuestas. Un buen planteamiento de diálogo e inclusión, al estilo de la apertura política de 1977, cuando el régimen venía de un triunfo aplastante sobre una oposición disminuida por un sistema de partido casi único y enorme poder centralizado, podría hacer transitar de mejor manera los cambios supuestos para “desmantelar el Estado neoliberal” y construir un eventual Estado de Bienestar que nos caería muy bien, pero no es poca cosa pretender, pues la economía debe, en principio, sostener una mejor distribución del ingreso con crecimiento y generación de empleos y riqueza para distribuir, tal como sucede en China o en Dinamarca. Iniciar sumando ayudaría mucho a la gente, a la economía, al TMEC y a la relación con el resto del mundo.

RUBICÓN Enrique del Val
Economista interesado en los temas de combate a la corrupción y la pobreza.

Europa lleva varios años en una situación económica complicada, y, a raíz de ello, la Comisión de la Unión Europea le encargó a Mario Draghi –banquero privado en sus orígenes, después presidente del Banco Central Europeo hasta convertirse por un corto tiempo en Primer Ministro de Italia–, que redacte un informe sobre el futuro de la economía en Europa, en momentos en que Alemania, Suecia y Austria están en recesión o estancadas, como Francia e Italia.
Este mes se ha publicado el informe y está causando un gran revuelo. En la revista digital Sin Permiso, tres de sus colaboradores, Thomas Piketty, Adam Tooze y Michael Roberts, lo comentan con opiniones varias y valdría destacar algunas, por la importancia que representan para el futuro de ese continente.
Quizás uno de los mejores párrafos del informe, mencionado por los expertos antes citados, es el que dice “Estas necesidades de inversión son enormes y sin precedentes desde una perspectiva histórica. Las necesidades de inversión de 750-800 mil millones de euros (anuales) para la Unión Europea corresponden al 4.4-4.7 del PIB de esta zona (al nivel de 2023). En comparación,
la inversión en el marco del Plan Marshall, de 1948 a 1952, ascendió al 1 al 2% del PIB”.
Piketty dice “el informe Draghi tiene el inmenso mérito de torcer el cuello al dogma de la austeridad presupuestaria” y, a pesar de su crítica de ser tecnófilo, le reconoce que es acertado en varias de las propuestas. Efectivamente, en varias partes del informe menciona, con datos concretos, cómo está Europa hoy en relación con los que creo considera sus mayores competidores, Estados Unidos y China.
Pone como ejemplo el caso de los operadores de telecomunicaciones. Tienen 34 operadores de redes móviles, mientras que los americanos tienen tres y los chinos cuatro. Los precios son más bajos en Europa por la competencia, lo cual beneficia a los consumidores, pero a la vez, dice Draghi, ha provocado que la rentabilidad de las empresas se haya reducido y, en consecuencia, también los niveles de desarrollo tecnológico e inversión, quedándose atrás en innovación.
Otro dato es el de inversión en Inteligencia Artificial. En 2023 se estima se invirtieron en Europa ocho mil millones de euros en capital de riesgo, en comparación con 68 mil millones en Estados Unidos y 15 mil millones en China.
Para Draghi, lo que llama un “desafío existencial”, es que el sector capitalista invierta más en nuevas tecnologías con créditos baratos, mercados desregulados y mayores incentivos fiscales, es decir, la más pura tradición neoliberal. Piketty aspira a que haya un debate y que si los cuatro países que reúnen a las tres cuartas partes de la población y del PIB europeo (Alemania, Italia, Francia y España) “logran llegar a un acuerdo sobre un compromiso equilibrado e inclusivo a nivel social y territorial, será posible avanzar…. Es este debate el que debe iniciarse”. Considero que el informe Draghi tiene el mérito de explicar la situación que se vive en ese continente, que se está quedando atrás bajo la pujanza de China, Estados Unidos y, pronto, India. También es un mensaje a los gobiernos que se están inclinando a la derecha, de que es necesario avanzar con más participación en la economía, más allá de dar apoyos a la iniciativa privada. Está demostrado que para el sector privado lo importante es la rentabilidad individual, y lo que ahora se necesita es rentabilidad social. Como indica el informe, se necesitan miles de millones de euros para estar a la altura de los desafíos, y solo el Estado lo puede hacer.



LA EVOLUCIÓN de los datos de salud pública muestra cambios en el gasto, la atención y la disponibilidad de personal médico en el país.
Porcentaje del gasto público en salud ejercido en el primer nivel
Los nuevos programas de la próxima Presidenta requieren de una inversión de 68 mil millones de pesos, según diputados; educación, elección de magistrados y la Secretaría de las Mujeres, los principales conceptos
TANIA ROSAS redaccion@ejecentral.com.mx
El Congreso de la Unión se perfila como un actor central en los primeros 100 días de gobierno de Claudia Sheinbaum, la primera mujer en ocupar la presidencia de México. Durante una reciente reunión, los legisladores y la nueva mandataria acordaron cinco prioridades legislativas que se prevén impactarán de manera significativa la economía del país.
Las propuestas incluyen la implementación de tres programas sociales: apoyo económico para mujeres de 60 a 64 años, becas para estudiantes de educación básica en escuelas públicas y atención médica a domicilio para adultos mayores. Además, se discutirá la reforma a la Ley Orgánica de la Administración Pública Federal y las leyes secundarias relacionadas con la reforma del Poder Judicial.
La magnitud de estos cambios demandará una asignación considerable de recursos que deberá reflejarse en el Presupuesto de Egresos de la Federación 2025. Sheinbaum tiene hasta el 15 de noviembre para presentar su proyecto de presupuesto, y según diputados de Morena consultados por ejecentral se estiman asignaciones por al menos 68 mil millones de pesos. De esta suma, 60 mil millones estarían destinados a los nuevos programas sociales, mil millones a la nueva Secretaría de las Mujeres, y siete mil millones para la selección de nuevos ministros, jueces y magistrados.
“En los primeros 100 días vamos a sentar las bases de la nueva constitucionalidad del segundo piso de la transformación. Va a haber un nuevo marco legal. Vamos a aprovechar el legado que el presidente Andrés Manuel López Obrador desarrolló a lo largo
de estos seis años”, comentó Alfonso Ramírez Cuéllar, vicecoordinador de los diputados de Morena. Esta perspectiva resalta la intención de continuar con la visión transformadora de la administración saliente, mientras se establece un nuevo enfoque hacia la movilidad social. Identificado como un aliado estratégico de Sheinbaum, Ramírez Cuéllar ha sido señalado como una pieza clave para la tramitación del presupuesto, recordando su rol crucial en 2018, cuando López Obrador asumió la presidencia y él lideraba la Comisión de Presupuesto en San Lázaro. Con una agenda que promete redibujar el mapa social y económico de México, los próximos días serán decisivos para la nueva administración.
legislativas
En una reciente entrevista con ejecentral Alfonso Ramírez Cuéllar, coordinador de los diputados de Morena, dejó claro que la agenda legislativa en las próximas semanas estará dominada por las reformas Claudia Sheinbaum. Estas reformas deben ser aprobadas a más tardar en noviembre para asegurar su inclusión en el Paquete Económico 2025.
Entre las iniciativas clave se encuentran la creación de la Secretaría de las Mujeres y la Secretaría de Ciencia, además de modificaciones a Segalmex, la integración de la Guardia Nacional a la Secretaría de la Defensa Nacional, y nuevos programas sociales que se implementarán desde el inicio



de su gobierno. Ramírez Cuéllar destacó que “después del primero de octubre, México va a abrir una nueva etapa, un nuevo gobierno”, caracterizado por un “piso parejo” y un enfoque en la movilidad social ascendente, que promueva el diálogo y el respeto a los derechos humanos.
Sin embargo, el coordinador Ricardo Monreal subrayó que los legisladores de Morena están comprometidos con la aprobación de las 18 reformas que el presidente Andrés Manuel López Obrador presentó el 5 de febrero. Estas deben ser consideradas durante el primer periodo ordinario de sesiones, que podría extenderse hasta el 31 de diciembre, aunque los morenistas buscan concluirlo el 15 de diciembre.
Estamos buscando llegar a 2030 sin ningún pobre extremo. Tenemos definida una estrategia clara para focalizar esfuerzos, especialmente en niños y niñas, tanto en zonas rurales como urbanas”.
Alfonso Ramírez Cuéllar, vicecoordinador de los diputados de Morena
Hasta la fecha, el Congreso ha avalado cinco de estas iniciativas: la reforma al Poder Judicial, la integración de la Guardia Nacional a la Secretaría de la Defensa, el reconocimiento de los pueblos indígenas y afromexicanos
Consultas externas en instituciones públicas (millones)
Consultas externas en instituciones públicas (millones de personas sin seguridad social) Número de médicos por mil habitantes
Número de enfermeras por mil habitantes
PRIORIDADES DE UN NUEVO GOBIERNO
CLAUDIA SHEINBAUM propone tres programas prioritarios que beneficiarán a mujeres, estudiantes y adultos mayores para mejorar la calidad de vida en México.
Apoyos para mujeres de 60 a 64 años: En 2025, habrá un millón de beneficiarias indígenas y afromexicanas, con un apoyo bimestral de tres mil pesos.
Becas para estudiantes de educación básica en escuelas públicas: Comenzará con apoyos de mil 300 pesos para alumnos de secundaria, buscando que en 2027 el programa sea universal.
9.1
MILLONES de mexicanos se encontraban en pobreza extrema en 2022, al comparar con los 8.7 millones en 2018.
como sujetos de derecho público, el aseguramiento de que el salario mínimo no esté por debajo de la inflación, y la constitucionalidad del programa Jóvenes Construyendo el Futuro.
Además, Monreal destacó la necesidad de apoyar a Sheinbaum en el diseño del Sistema Nacional de Cuidados, que busca promover una mayor equidad laboral, acelerar la transformación de escuelas de tiempo completo en zonas vulnerables, y establecer centros públicos de cuidados y educación inicial para la primera infancia. Arturo Ávila, vocero de la bancada de Morena en San Lázaro, anticipó la propuesta de 19 reformas constitucionales que abren la puerta a un futuro más equitativo. “La doctora Sheinbaum tendrá, por ejemplo, el plan más ambicioso de la historia del México moderno con las visitas médicas domiciliarias”, resaltó Ávila, indicando que más de 25 mil médicos estarán involucrados en este sistema de prevención de enfermedades, llevando la atención médica directamente a los hogares de los mexicanos. Con estas reformas, se espera que el nuevo gobierno no solo marque un cambio de estilo, sino una transformación estructural en el territorio mexicano.
Programa ‘Hoy por ustedes, mañana por nosotros’: Permitirá que médicos acudan a domicilios para atender a 12 millones de adultos mayores.
POR LA EQUIDAD
CLAUDIA SHEINBAUM presenta iniciativas para mejorar el bienestar infantil y la equidad de género, buscando una transformación en la educación y el apoyo a las familias.
Crear centros públicos de cuidados y educación inicial para la primera infancia.
Priorizar a jornaleras agrícolas y a las mujeres de la maquila.
Incrementar de manera paulatina las licencias de maternidad y paternidad.
Los retos
El nuevo gobierno de Claudia Sheinbaum enfrenta un reto monumental: la distribución de los recursos públicos. Este desafío se vuelve aún más crítico a medida que los compromisos dejados por Andrés Manuel López Obrador absorben gran parte del Presupuesto de Egresos de la Federación 2025.
Según miembros de la Cuarta Transformación (4T), la Secretaría de Hacienda continúa trabajando en el Paquete Económico, y ya se ha descartado la posibilidad de una reforma fiscal.
En su lugar, se enfocan en la redistribución de los recursos disponibles. Sin embargo, no se ha presentado una estrategia clara para incrementar la disponibilidad de fondos públicos, lo que plantea preguntas sobre cómo se cumplirán las promesas de Sheinbaum frente a los compromisos heredados, como el programa de Pensión para el Bienestar de Adultos Mayores, cuyo costo estimado asciende a 583 mil millones de pesos, según los Precriterios Generales de Política Económica 2025. El documento titulado 100 pasos para la transformación detalla los compromisos de
Promover una mayor equidad laboral y corresponsabilidad entre los hogares, la sociedad y el Estado.
Acelerar la conversión a escuelas de tiempo completo en zonas con mayores carencias.
Sheinbaum y sus propuestas para lograr sus objetivos. Incluye la continuidad de la austeridad republicana, que permitió ahorrar tres mil 85 millones de pesos en 2022. La presidenta plantea una mejora en la recaudación de impuestos como una solución fundamental, apoyándose en políticas públicas innovadoras y el uso de tecnología para minimizar la evasión fiscal. “Se mejorará la recaudación con estrategias de inteligencia fiscal para fomentar el pago oportuno, incrementar la base tributaria sin aumentar tasas ni crear nuevos impuestos, y mejorar la presencia fiscal”, señala. Sin embargo, su plan no incluye un cálculo sobre cuántos recursos se podrían obtener ni en qué plazo se lograría.
Con la presión de equilibrar los compromisos previos y los nuevos proyectos, Sheinbaum deberá mostrar su capacidad para gestionar los recursos de manera eficiente, o podría enfrentar tensiones políticas y sociales en su intento de transformar la estructura económica de México.
En la agenda del nuevo Congreso de la Unión, la legislación secundaria al Poder Judicial se presenta como una de las principales prioridades. Este esfuerzo se realizará
›Un objetivo ambicioso de esta administración es la eliminación de la pobreza extrema, un desafío que ha eludido a anteriores gobiernos.
LA ADMINISTRACIÓN ACTUAL SE COMPROMETE A ELIMINAR LA POBREZA EXTREMA, UN DESAFÍO NO RESUELTO POR GOBIERNOS ANTERIORES.
en estrecha coordinación con el gobierno de Claudia Sheinbaum, quien ha expresado su compromiso con una transformación del sistema judicial mexicano. Los legisladores de oposición han expresado preocupaciones sobre los conflictos políticos y legales que podría generar esta reforma. Un punto crítico es la financiación de las elecciones de jueces, ya que Morena y Sheinbaum proponen usar recursos de los fideicomisos de la Suprema Corte, que no se han podido eliminar legalmente. En entrevista con ejecentral la diputada de Morena y exsubprocuradora Jurídica de la Procuraduría General de la República, Mariana Benítez Tiburcio, subrayó que la obligación de los legisladores es aprobar las leyes secundarias antes de diciembre. En este periodo también se etiquetarán los recursos necesarios para la elección de ministros, jueces y magistrados. Benítez anticipó que en 2025, Sheinbaum presentará su propuesta para fortalecer las fiscalías y defensorías públicas, lo que marcará una segunda fase de transformación del Poder Judicial. “Va a ser una reforma igual, prioritaria, pero en este periodo no creo que llegue”, comentó. Esta segunda fase se enfocará en la procuración de justicia, un ámbito que Benítez considera urgente, dada la significativa rezago existente, especialmente en las fiscalías estatales, las cuales investigan aproximadamente el 90% de los delitos en el país. La reforma al Poder Judicial se presenta no solo como un reto legislativo, sino como un test crucial de la capacidad de Sheinbaum y su administración para implementar cambios significativos en un sistema que ha sido objeto de críticas durante años. Con la oposición en alerta y el tiempo en su contra, el gobierno deberá maniobrar con cuidado para evitar tensiones políticas que podrían obstaculizar su agenda transformadora.
¿Sello propio o continuidad?
La propuesta del gobierno de construir un “segundo piso” de oportunidades busca transformar el sistema actual, priorizando un entorno equitativo que fomente el crecimiento económico y elimine disparidades en el acceso a servicios básicos y derechos para todos.
Claudia Sheinbaum, primera presidenta de México, alista reformas clave en su gobierno.”

A medida que Claudia Sheinbaum asuma la presidencia, se enfrenta a un desafío monumental: consolidar su propia identidad política mientras promete dar continuidad a la transformación iniciada por Andrés Manuel López Obrador. Aunque ha ratificado a varios funcionarios nombrados por su predecesor, diputados clave como Alfonso Ramírez Cuéllar, Ricardo Monreal y Mariana Benítez afirman que Sheinbaum no es una extensión de López Obrador, y que su liderazgo se medirá a partir de sus acciones en los primeros 100 días de gobierno. Mariana Benítez enfatizó la presión que enfrentará la nueva presidenta desde el primer día. “La van a juzgar y criticar debido a la polarización existente”, señaló. Además, destacó que estas críticas a menudo son machistas, buscando descalificar a una mujer en el poder. “Estamos iniciando una nueva era, donde las mujeres ocupan las posiciones más altas de poder en este país”, afirmó. Ramírez Cuéllar indicó que la transformación busca construir un “segundo piso” de oportunidades al “crear piso parejo y generar igualdad de oportunidades y derechos para todos”. Uno de los objetivos ambiciosos de esta gestión es la eliminación de la pobreza extrema, un desafío que ha eludido a anteriores gobiernos. Un objetivo ambicioso es eliminar la pobreza extrema, que ha aumentado de 8.7 a 9.1 millones entre 2018 y 2022, según el Consejo Nacional de Evaluación de la Política de Desarrollo Social (Coneval). Frente a la pregunta de cómo planean acabar con la pobreza extrema, Ramírez Cuéllar afirmó: “Estamos buscando llegar a 2030 sin ningún pobre extremo. Tenemos definida una estrategia clara para focalizar esfuerzos, especialmente en niños y niñas, tanto en zonas rurales como urbanas”. Resaltó la importancia de fortalecer los ingresos de los hogares mexicanos a través de mejoras salariales, reparto de utilidades y políticas sociales consistentes. La etapa que se abre con Sheinbaum promete ser decisiva. A medida que la nueva presidenta navega por la polarización política y las expectativas sociales, el éxito de su administración podría depender de su capacidad para forjar un camino que no solo continúe la transformación, sino que también lo redefine en términos de inclusión y equidad. Con un enfoque claro y metas ambiciosas, la administración de Sheinbaum se prepara para dejar su huella en la historia de México.
LA PRIMERA PRESIDENTA DE MÉXICO tomará protesta en un evento protocolario marcado por la vigilancia y manifestaciones en contra Esto es lo que se prevé para el 1 de octubre
• Sesión en la Cámara de Diputados a las 9 a.m. López Obrador entregará la banda presidencial.
• Ifigenia Martínez colocará la banda presidencial a la jefa del Ejecutivo ante mil invitados.
• Se prevén protestas afuera de la Cámara por el Frente Cívico Nacional y otros grupos.
• Sheinbaum almorzará en Palacio Nacional con líderes políticos y empresariales.
• Por la tarde, dará un mensaje en el Zócalo.
Ante mil invitados, la nueva jefa del Ejecutivo rendirá protesta el 1 de octubre en San Lázaro, durante un evento que despertará el apoyo entusiasta de sus seguidores y también la protesta de sus opositores
TANIA ROSAS redaccion@ejecentral.com.mx
Claudia Sheinbaum rendirá protesta como presidenta de México el próximo 1 de octubre en la Cámara de Diputados, marcando un momento histórico al ser la primera mujer en asumir el cargo más alto del país. El evento contará con la presencia de mil invitados, incluidos presidentes y expresidentes de América Latina, diplomáticos, empresarios, legisladores y los gabinetes entrante y saliente. La sesión está programada para las 9 de la mañana.
La ceremonia seguirá el protocolo en el que el jefe del Ejecutivo saliente, Andrés Manuel López Obrador, entregará la banda presidencial a la presidenta de la Cámara de Diputados, Ifigenia Martínez, quien se encargará de colocarla a Sheinbaum. El acto es significativo, no sólo por el traspaso de poder, sino porque será la primera vez que una mujer imponga la banda presidencial a otra mujer en México, un símbolo destacado por varios sectores políticos.
En cuanto a la seguridad, no se contempla una sede alterna para la ceremonia, por lo que se desplegará un dispositivo amplio para asegurar el acceso y evitar que posibles manifestaciones interfieran con el evento.
Desde el 1 de septiembre, personal militar y de seguridad pública federal ha trabajado en la logística para garantizar la asistencia sin contratiempos de López Obrador y Sheinbaum al Palacio Legislativo de San Lázaro.
Arturo Ávila, diputado y vocero de Morena, declaró que no existe un “Plan B” para la sesión y confía en que la oposición mantenga un “comportamiento republicano”. Ávila también enfatizó la importancia del evento al señalar que es el cierre del mandato de López Obrador, a quien describió como una figura clave en la transformación del país. “Viene una transformación más profunda, con cambios importantes y alrededor de 19 reformas constitucionales en los próximos meses”, añadió.
Pese a los preparativos oficiales, el Frente Cívico Nacional, a través de su vocero Fernando Belaunzarán, mantiene su plan de organizar manifestaciones pacíficas para que la toma de protesta se realice en un recinto distinto. Belaunzarán insiste en que su grupo no permitirá que Sheinbaum reciba la banda presidencial en San Lázaro y destaca que su lucha es por la preservación de la democracia, que a su juicio está en riesgo de convertirse en una tiranía.
El Frente ha convocado a sus simpatizantes a marchar y bloquear los accesos a la Cámara de Diputados el 1 de octubre. No obstante, Belaunzarán subrayó que la movilización será pacífica y que ellos mismos se encargarán de cuidar a los manifestantes para evitar actos de violencia. “Nuestra lucha siempre será pacífica, de eso pueden estar seguros”, aseguró. Sin embargo, su discurso deja clara la preocupación por lo que consideran la instauración de una dictadura en el país.
El contexto de estas manifestaciones está vinculado a la reciente aprobación en fast track de la reforma al Poder Judicial, lo que ha sido interpretado por sectores de la oposición como un indicio de

Tras el acto protocolario en el Palacio Legislativo, Sheinbaum encabezará un evento masivo en el Zócalo capitalino por la tarde, siguiendo el estilo de López Obrador.
que se buscan consolidar cambios que ponen en riesgo la independencia de las instituciones. Según Belaunzarán, este tipo de reformas pone en peligro acuerdos internacionales como el T-MEC, lo que, junto con la situación económica del país, podría desencadenar una crisis mayor.
Por su parte, Ricardo Monreal, coordinador de los diputados de Morena, expresó su esperanza de que el 1 de octubre prevalezca la “racionalidad” y que no se presenten mayores complicaciones para la toma de protesta de Sheinbaum.
Monreal ha sido una de las figuras clave en asegurar que haya condiciones para que tanto Sheinbaum como López Obrador puedan acudir a San Lázaro sin contratiempos, y evitar confrontaciones como las que marcaron la toma de protesta de Felipe Calderón en 2006.
Tras el acto protocolario en el Palacio Legislativo, Sheinbaum se reunirá con líderes políticos nacionales e internacionales en Palacio Nacional, y por la tarde se
espera que encabece un evento masivo en el Zócalo capitalino, siguiendo el estilo de López Obrador. Este acto ante el pueblo será simbólico, consolidando su llegada a la presidencia en un escenario que ha sido emblemático para el actual gobierno. Belaunzarán concluyó que, aunque las protestas del Frente Cívico Nacional están previstas para el 1 de octubre, también están abiertos a coordinarse con otras organizaciones civiles que planteen alternativas de acción. “Estamos comprometidos con la unidad de la oposición, tanto social como partidaria”, afirmó, dejando abierta la posibilidad de modificar sus planes si surge una propuesta con mayor consenso. El próximo 1 de octubre será, sin duda, una fecha relevante en la historia política del país, no sólo por el cambio de gobierno, sino por las tensiones entre las distintas fuerzas políticas que buscarán imponer su visión en un escenario de transición marcado por reformas y movilizaciones ciudadanas.
ENTRE LAS ACCIONES prioritarias del Gabinete de Seguridad para el primer trimestre se incluye un programa focalizado en los 10 municipios que concentran el 25% de los homicidios vinculados a la delincuencia organizada, iniciando en Tijuana, León, Celaya, Acapulco, Benito Juárez y Colima.
JONATHAN NACAR jonathanjnd@ejecentral.com.mx
La consolidación del Sistema Nacional de Inteligencia (SNI) para la seguridad, y el fortalecimiento de las labores de investigación se perfilan como la piedra angular en la estrategia de seguridad de la presidenta Claudia Sheinbaum Pardo. Así lo señala un diagnóstico sobre la “Estrategia de Seguridad de los Primeros 100 días” del gobierno que arranca este martes, en el cual se delinean algunos de los objetivos y acciones prioritarias para el Gabinete de Seguridad en el primer tramo de la nueva administración.
Especialistas consultados por ejecentral señalaron que si bien el documento con las firmas de la Secretaría de la Defensa Nacional (Sedena), la Secretaría de Marina (Semar) y la Secretaría de Seguridad y Protección Ciudadana (SSPC) no se dio a conocer formalmente, sí es acorde a los compromisos planteados por la mandataria y el próximo titular de Seguridad y Protección Ciudadana, Omar García Harfuch, desde el periodo de campaña.
“La estrategia que promoveremos será atender las causas, consolidar la Guardia Nacional y su coordinación con policías estatales. Vamos a fortalecer la inteligencia y la investigación y el trabajo conjunto para reducir la impunidad”, señalaba la entonces candidata de Morena, PT y PVEM en el documento 100 pasos para la Transformación, publicado en marzo pasado.
En el marco de la toma de protesta de la presidenta Claudia Sheinbaum, dichos compromisos se encaminan en objetivos concretos que incluyen: la disminución de la incidencia de homicidios dolosos y delitos de alto impacto, así como mejorar la percepción ciudadana sobre el respaldo del gobierno ante hechos violentos.
También neutralizar generadores de violencia y redes criminales: atención a zonas con alta criminalidad; combate al tráfico de drogas –particularmente fentanilo–, armas y lavado de dinero, todo ello encaminado para la lograr la “pacificación del país”, señala el documento.
Estrategias emergentes
Según el diagnóstico, entre las “acciones prioritarias” del Gabinete de Seguridad para el primer trimestre de la administración, se plantean cinco “estrategias emergentes”: un programa focalizado en los 10 municipios del país que concentran 25% de los homicidios vinculados a la delincuencia organizada, iniciando de

›La reforma permitirá a los militares integrarse plenamente a la Guardia Nacional como apoyo al Ministerio Público en la lucha contra el crimen.
El plan de seguridad del nuevo gobierno prioriza la consolidación del Sistema Nacional de Inteligencia y la coordinación entre fuerzas federales y locales para combatir la delincuencia y reducir la violencia

manera prioritaria en los municipios de Tijuana, León, Celaya, Acapulco, Benito Juárez y Colima.
La implementación de una “estrategia operativa y de atención a las causas” en los municipios más violentos de Chiapas; atención a la extorsión en el ciclo de producción del limón en Michoacán, particularmente en la región de Tierra Caliente. Y una estrategia con “notoria presencia” en carreteras y vías generales de comunicación en todo el país; y la conformación de 10 grupos de Fuerzas de tarea, integrada por las autoridades federales para “actividades de inteligencia y actos de investigación que deriven en judicializaciones”.
Para Jonathan Maza Vázquez, director de estrategia e Inteligencia en Stratop Risk Consulting, el hecho de que la articulación del Sistema Nacional de Inteligencia para la seguridad pública y la seguridad nacional se perfile como “la columna vertebral” de las acciones en seguridad es un giro importante para disminuir la violencia por los enfrentamientos entre grupos criminales y la incidencia delictiva. Sin embargo, el también maestro en Seguridad Nacional por el Colegio de

Defensa Nacional subrayó la necesidad de que el Congreso legisle en la materia a fin de que “los productos de inteligencia de las agencias del Estado mexicano se integren a carpetas de investigación y puedan ser vinculantes a procesos y sentencias”. El uso de inteligencia de las agencias como el Centro Nacional de Inteligencia para el seguimiento de objetivos criminales está estipulada en la Ley de Seguridad Nacional, pero sólo puede integrarse a una carpeta de investigación con la aprobación de un juez, lo cual ha sido “un dolor de cabeza para las autoridades, especialmente para concretar las detenciones”, explicó Maza.
Guarda Nacional, una aliada
La aprobación del dictamen que coloca a la Guardia Nacional bajo el mando de la Sedena es fundamental para que este cuerpo realice tareas de inteligencia e investigación en la nueva Estrategia Nacional de Seguridad Pública.
Jonathan Maza destaca que la reforma permite a los militares integrarse plenamente a la Guardia Nacional como apoyo al Ministerio Público en la lucha contra el crimen, junto con las policías locales.
“Estamos presenciando un proceso de transformación que podría construir una identidad propia para la Guardia Nacional. Tendrá labores de investigación e inteligencia, pero se requiere también una reforma en materia de inteligencia”, comentó Maza.
La estrategia enfatiza la coordinación entre el Gabinete de Seguridad para definir acciones y metas, así como la “aprobación” de los secretarios de Seguridad Pública estatales. Maza señala que no se debe confundir la “centralización de la seguridad pública” con la asunción total de responsabilidad del gobierno federal ante la “incapacidad de las autoridades locales”.
Asimismo, resaltó la importancia de que el Sistema Nacional de Seguridad Pública evolucione y la responsabilidad de los 32 gobernadores en establecer estándares junto a las fiscalías, ya que la seguridad pública está vinculada a la investigación de delitos y a la impartición de justicia.
Es un giro importante la articulación del Sistema Nacional de Inteligencia para la seguridad pública y nacional se perfile como la columna vertebral de las acciones en seguridad.”
Jonathan Maza Vázquez, director de estrategia e Inteligencia en Stratop Risk Consulting.
LA PERMANENCIA de Rogelio Ramírez de la O en Hacienda brinda señales de estabilidad, y genera confianza en la promesa de mejorar la situación económica”, afirma Alejandra Macías del CIEP.

›Hasta 14% fue el aumento en la inversión pública proyectada para 2025, destinado a impulsar el crecimiento económico y fortalecer sectores clave como salud, educación e infraestructura.
El gobierno entrante busca avanzar en transición energética, austeridad y modernización de Pemex, pero enfrenta desafíos fiscales que obligarán a decisiones difíciles en gasto público e ingresos
JONATHAN NÁCAR
jonathanjnd@ejecentral.com.mx
El plan financiero de Claudia Sheinbaum para el “segundo piso de la cuarta transformación” busca mantener la austeridad republicana y una disciplina fiscal estricta. Con sus “100 pasos para la transformación”, la presidenta tiene como objetivo consolidar el estado de bienestar, avanzar en la transición energética y combatir la corrupción. Sin embargo, estos objetivos enfrentan grandes retos fiscales que complican su implementación.
Alejandra Macías Sánchez, directora del Centro de Investigación Económica y Presupuestaria (CIEP), señala que es necesario implementar una reforma fiscal y redistribuir el gasto público para garantizar estabilidad económica. La falta de espacio fiscal obliga al gobierno a ajustar ingresos y gastos, y tomar decisiones difíciles para reducir el endeudamiento. Según Macías, revisar la situación de Pemex y mejorar la recaudación de impuestos son claves en este proceso. Las prioridades del nuevo gobierno incluyen la transición energética, la modernización de Pemex y la continuación de programas sociales como las pensiones para adultos mayores. Sin embargo, reducir el déficit fiscal del 5.9% al 3% será un desafío, ya que exigirá recortes de gasto o aumentos en ingresos. Además,
Macías insiste en que el cambio climático debe ser una prioridad dentro de la transición energética.
Pese a los avances como el aumento del salario mínimo y la reforma de pensiones, el nuevo gobierno enfrenta incertidumbre económica, especialmente durante sus primeros 100 días. Aunque la permanencia de Rogelio Ramírez de la O en la Secretaría de Hacienda ofrece cierta confianza, las reformas y el próximo paquete económico generan preocupación en los mercados.
El contexto internacional añade más presión, en particular con la próxima elección presidencial en Estados Unidos, que podría afectar las relaciones comerciales y la calificación crediticia de México. La falta de inversión en sectores clave, como salud y educación, significa un riesgo en los primeros meses del nuevo gobierno.
El gobierno de Claudia Sheinbaum prioriza la transición energética y la modernización de Pemex para reducir la dependencia de combustibles fósiles y avanzar hacia una economía más verde. También busca fortalecer el estado de bienestar, continuando la “reorientación social” hacia programas como las pensiones para adultos mayores y combatiendo la corrupción con austeridad republicana. Alejandra Macías advierte que las finanzas públicas son un obstáculo importante. Para reducir el déficit fiscal del 5.9%

La economista también destaca la necesidad de redirigir recursos hacia sectores clave como salud, educación y la atención a la primera infancia. En su opinión, gran parte del presupuesto está actualmente enfocado en energía y pensiones, lo que deja poco espacio para inversiones en otros rubros esenciales.
La modernización de Pemex, una de las principales metas dentro de los “100 pasos” de Sheinbaum, requiere una revisión profunda. Macías resalta que la empresa estatal debe alinearse con las demandas de una economía más sostenible y ecológica, acorde con los compromisos internacionales adquiridos por México.
Además, la falta de inversión en temas como el cambio climático es otro desafío que el nuevo gobierno debe enfrentar. Según Macías, no ha habido un flujo de recursos suficiente en este ámbito, lo que podría generar problemas a medida que las afectaciones climáticas se hacen más evidentes en el país.
El gobierno de Claudia Sheinbaum comienza con algunos logros en materia económica, como el aumento del salario mínimo y la reforma de pensiones. Sin embargo, persisten varios desafíos importantes que enfrentar en los primeros 100 días, entre ellos la incertidumbre en los mercados generada por los rápidos cambios en esta transición de gobierno. La permanencia de Rogelio Ramírez de la O en Hacienda ha brindado señales de estabilidad en la promesa de reducir el déficit. Sin embargo, el paquete económico y las reformas pendientes generan inquietud. Alejandra Macías, del CIEP, advierte que sin ajustes en el presupuesto, será complicado operar el próximo año, y las calificadoras están atentas a estos temas.
5.9
POR CIENTO es el déficit fiscal actual, por lo que se busca reducir al tres por ciento.
al 3%, será necesario tomar decisiones complejas, como reducir el gasto o aumentar ingresos. Macías enfatiza que no se trata solo de aumentar impuestos, sino de revisar la situación de Pemex y reestructurar el gasto en pensiones.
1.5
POR CIENTO es el incremento en la recaudación de impuestos necesario para estabilizar las finanzas públicas.
El panorama económico internacional también añade presión. La elección presidencial en Estados Unidos podría tener efectos en las relaciones comerciales y en la calificación crediticia de México, según analistas. Esto coloca al país en una posición vulnerable ante los cambios externos que podrían afectar su estabilidad financiera.
Macías Macías subrayó la falta de inversión en sectores clave, como los servicios de salud, que podría ser un problema en los primeros meses del nuevo gobierno. Este “foco amarillo” es una alerta que no debe ser ignorada si se busca estabilidad a largo plazo. Así, los desafíos internos y externos serán cruciales para el futuro económico del país.
LOS RECORTES a a los presupuestos de Semarnat, Profepa, Conafor, la Comisión Nacional de Áreas Naturales Protegidas y la Conabio, las llevaron a situaciones de inoperancia con graves impactos para los ecosistemas del país y las comunidades que los habitan.
›Los logros de la Conabio están ahora en riesgo si dicha comisión intersecretarial queda reducida a una dependencia marginal subordinada a la Semarnat.
Aunque en este ámbito, la nueva jefa del Ejecutivo enfrenta un panorama complicado, especialistas ven señales de esperanza en el nombramiento de sus secretarios
MANUEL LINO GONZÁLEZ mlino6@gmail.com
El punto de partida en materia de medio ambiente para la próxima administración es dramático, no sólo por el deterioro ambiental que ya se ha dado, sino porque las instituciones dedicadas a la materia han sido “debilitadas” y sus capacidades “erosionadas” en el sexenio que hoy concluye, se señala en la Agenda socioambiental 2024: diagnósticos y propuestas , coordinada por Leticia Merino y Cecilia Navarro, y elaborada por 35 autoras y autores.
Sin embargo, la presencia de las próximas titulares de la Secretaría de Medio Ambiente y Recursos Naturales (Semarnat), Alicia Bárcena; de la Procuraduría Federal de Protección al Ambiente (Profepa), Mariana Boy, y de una representante de Rosaura Ruiz, quien encabezará la próxima Secretaría de Ciencia, Humanidades, Tecnología e Innovación, en la presentación de la Agenda el viernes 20 de septiembre en la UNAM ha sido entendida como una señal de que sus propuestas podrían ser atendidas.
A finales de la semana pasada, Bárcena
dio a conocer las Prioridades para Semarnat 2024-2030, mismas que coinciden en algunos puntos con la Agenda Socioambiental, ya que el primero de los objetivos en la lista es implementar una estrategia de restauración, y el segundo, hacer planes de remediación en diversas cuencas.
Agua, diagnóstico demoledor
En la sección Conclusiones de la Agenda, Leticia Merino, señala que “los procesos de destrucción y deterioro de territorios, ecosistemas y recursos (...) permanecen y, en casi todos los temas, se han profundizado”. “Lejos de ser prioridad del gobierno que concluye en 2024, los temas ambientales fueron aún más relegados, los presupuestos de las instituciones ambientales se desplomaron. Peor aún, en medio de los recortes, más del 80% del presupuesto ambiental se destinó a la Conagua, a pesar de su notoria corrupción y sometimiento a los intereses de los grandes concesionarios acaparadores del agua”, señala Merino.
Según Elena Burns, desde su creación en 1989, la Comisión Nacional del Agua (Conagua) ha sido “una institución vertical y opaca”, en la que “predomina una dinámica de ‘decisiones por desastre’, que consiste en ignorar la prevención, provocar una crisis y luego exigir recursos
Vale también mencionar… el marcado deterioro de las ins-tituciones ambientales, con recortes muy drásticos a los pre-supuestos de Semarnat, Profepa, Conafor, la Comisión Nacional de Áreas Naturales Protegidas y por supuesto la Conabio”. Leticia Merino en la presentación de la Agenda Socioambiental 2024.
PRESUPUESTO FISCAL CONAFOR 2005-2024 (MILLONES DE PESOS)
LA DISMINUCIÓN DEL PRESUPUESTO del sector ambiental afecta notablemente la operación institucional, se señala en la Agenda.
Presupuesto Conafor (original) Presupuesto Conafor (deflactado)
Fuente: SHCP, Análisis programático del Presupuesto de Egresos de la Federación
LA REDUCCIÓN en la posibilidad de producir madera de manera legal es, junto con la entrada del crimen organizado al sector, uno de los factores que ha conducido al crecimiento de la tala ilegal.
agua potable y saneamiento para las familias de escasos recursos, la rehabilitación de plantas de tratamiento de aguas residuales y la actualización de dos normas ambientales relacionadas con el manejo del agua.
“Los cambios tendrán que sustentarse en una ciudadanía articulada, la voluntad del Ejecutivo y el buen funcionamiento de la Ley General del Aguas”, señala Merino.
Biodiversidad y viabilidad social
Otros signos importantes de debilitamiento, se señala en el documento, han sido “la integración de funcionarios sin experiencia y la subordinación del sector ambiental a las decisiones de gobiernos y grupos empresariales” (...) que han conducido a la erosión de las capacidades de la Semarnat y sus agencias para hacer cumplir de manera suficiente las prescripciones del marco legal y regulatorio”.
El ejemplo más dramático de las consecuencias está en la agenda forestal, pues se han socavado “las estructuras de apoyo a las comunidades y organizaciones locales productivas que impulsan las actividades de restauración, manejo sostenible y conservación de la biodiversidad, los ecosistemas y los recursos naturales”.
Para colmo, “la desestructuración de las organizaciones locales, así como los ataques a las organizaciones civiles que las acompañan, la merma continua de los recursos y capacidades de las instituciones, han favorecido la presencia creciente de grupos armados que actualmente controlan los territorios”.
Fuente:
Comisión Nacional Forestal
ilimitados para alguna solución sin realizar un análisis preliminar costo-beneficio, ni la planeación de un proyecto ejecutivo o la ejecución de alguna licitación previa”. Por otra parte, el equipo autoral de la Agenda reconoce que hubo avances en materia de agua durante esta administración, pero los califica de “magros” en comparación con las necesidades, como la ampliación de la cobertura de servicios de
La Agenda Socioambiental 2024 cubre muchos otros temas, como el energético, donde se señala, por ejemplo, que en 2022 la matriz energética seguía dominada en 87% por combustibles fósiles” y que “(d) escontando el consumo de Pemex, México importa de EU casi el 90% del gas que consume”; en minería se destaca la propuesta de elevar a rango constitucional la prohibición de realizar esta práctica a cielo abierto, entre otros temas.
En las prioridades dadas a conocer por Bárcena, destacan las intenciones de restaurar al menos 5% de los manglares del país para 2025 y 30% para 2030; recuperar de 15% de lagunas costeras en ocho estados; la reducción de la deforestación en nueve estados; la eliminación de minería en áreas naturales protegidas, y la creación de un parque industrial de economía circular en Quintana Roo para procesar sargazo.
BET-BIRAÍ NIETO MORALES bnieto@ejecentral.com.mx
EN MEDIO DE UNA DE LAS REFORMAS más polémicas del sexenio, Omar García Harfuch ha emergido como una de las voces más determinantes en la transformación de la estrategia de seguridad pública en México.
Su defensa vehemente de la incorporación de la Guardia Nacional (GN) a la Secretaría de la Defensa Nacional (Sedena) no es sólo una postura política; es parte de su visión estratégica para el país. Para García Harfuch, consolidar a la GN bajo el mando de la Sedena es la vía más efectiva para fortalecer esta institución y garantizar su permanencia y profesionalización.
García Harfuch, quien está a punto de recibir el nombramiento como titular de la Secretaría de Seguridad y Protección Ciudadana (SSPC) bajo el gobierno de Claudia Sheinbaum, asegura que este traspaso no representa una militarización del país.
En su intervención, subrayó que la SSPC seguirá siendo la entidad encargada de diseñar la estrategia de seguridad y coordinar el Gabinete de Seguridad, con el fin de mantener un equilibrio entre la operatividad militar y el respeto a los derechos humanos. Su visión a largo plazo incluye un enfoque integral que involucra tanto a la Guardia Nacional como a los estados y a las instancias de investigación e inteligencia.
›La propuesta de García Harfuch incluye la creación de una Subsecretaría de Inteligencia e Investigación dentro de la SSPC, un avance significativo en el combate a la delincuencia organizada.
Además, destacó la importancia de incorporar más analistas, investigadores de campo y especialistas técnicos para reforzar las capacidades de investigación en México.
Este enfoque, inspirado en cuerpos policiales exitosos en países como Chile, Italia, Francia y España, pretende mejorar la solidez de las investigaciones y garantizar una mayor efectividad en el combate al crimen.
El plan de García Harfuch se posiciona como una pieza clave dentro del proyecto de seguridad de Claudia Sheinbaum, cuyo objetivo no sólo es atender las causas de la violencia, sino también reforzar las capacidades operativas e investigativas de las fuerzas de seguridad.
Esta estrategia busca la coordinación total entre los diversos niveles de gobierno y las 32 entidades federativas, un punto que García Harfuch considera crucial para enfrentar los crecientes retos de seguridad en México.
No obstante, la visión de García Harfuch ha recibido críticas. En una maratónica sesión en el Senado de la República, que duró más de ocho horas, la reforma constitucional para traspasar a la GN a la Sedena fue aprobada con 86 votos a favor y 42 en contra.

20
ARTÍCULOS constitucionales forman parte del paquete enviado por el mandatario el 5 de febrero como parte de su nueva iniciativa.
120
MIL
efectivos integran la Guardia Nacional, aunque se espera que ascienda esta cifra a 150 mil para 2025.
: OMAR GARCÍA HARFUCH propone que la Guardia Nacional opere bajo la Sedena, para fortalecer la protección ciudadana en México sin perder la visión en derechos humanos y la coordinación entre diferentes niveles de gobierno
¿EN QUÉ CONSISTE LA REFORMA A LA GUARDIA
LOS CAMBIOS CONSTITUCIONALES consolidan mando militar en la Guardia Nacional, parte del plan del presidente López Obrador
К La reforma a la Guardia Nacional fue aprobada por los diputados el pasado 19 de septiembre.
К Los cambios consolidan legalmente el mando militar en la institución, cumpliendo el deseo del presidente López Obrador desde su creación.
К La iniciativa es parte de un paquete de 20 reformas constitucionales enviadas
por el mandatario el 5 de febrero.
К Se modifican los artículos 13, 16, 21, 32, 55, 73, 76, 78, 82, 89, 123 y 129 de la Constitución.
К La reforma del artículo 21 adscribe a la Guardia Nacional a la Sedena y la define como una fuerza de seguridad pública de carácter permanente, integrada por personal militar con formación policial.
EL DATO.
Con la reforma aprobada, el siguiente paso será su ratificación en los 32 congresos estatales.
К Desde su creación en 2019, la Guardia Nacional fue planteada con un mando civil en la Secretaría de Seguridad Pública, pero se permitió la incorporación de elementos militares a través de artículos transitorios.
La oposición, conformada por los partidos PAN, PRI y Movimiento Ciudadano, acusó al gobierno de Andrés Manuel López Obrador de militarizar al
país, argumentando que esta medida refuerza el control militar sobre la vida pública y representa un retroceso en el avance hacia una policía civil.
Pese a las críticas, García Harfuch ha mantenido su postura. Desde su perspectiva, la seguridad pública en México necesita una estructura sólida y permanente, y la Guardia Nacional, bajo el mando de la Sedena, es una respuesta viable ante los retos actuales de violencia e inseguridad.
El otrora secretario de Seguridad de la Ciudad de México ha defendido que la GN no debe verse como una fuerza militarizada, sino como una institución profesional con una formación que combina disciplina militar y doctrina policial, manteniendo siempre el respeto a los derechos humanos bajo estricta regulación.
Con la reforma aprobada, el siguiente paso será su ratificación en los 32 congresos estatales. Mientras tanto, el debate sobre el futuro de la seguridad en México continúa, y figuras como García Harfuch desempeñan un papel central en la definición de una estrategia que busca equilibrar las preocupaciones de la oposición con la necesidad de transformar la seguridad en el país.
HECHOS Y NOMBRES

Los apoyos de la
Alejandro Envila Fisher
@EnvilaFisher
Mañana, después de que rinda protesta y envíe su primer mensaje como presidenta constitucional, México empezará a conocer a la verdadera Claudia Sheinbaum Pardo, pues lo visto hasta ahora, incluso tras su victoria del 2 de junio, es una actuación necesaria para asegurarse de cruzar su propio Rubicón: el 1 de octubre.
Como candidata y aún después de su triunfo, Sheinbaum ha recorrido un camino particularmente complicado. La crítica, dentro y fuera de su partido, dentro y fuera del gobierno, ha sido descarnada. Lo menos que le han cuestionado es una completa subordinación a López Obrador, no tener margen de maniobra y parecer, más que la presidenta electa, la administradora de un proyecto ajeno, con nulo poder de decisión.
Los comentarios publicados en el órgano oficial de difusión de la 4T después del primer debate presidencial ilustran el fuego amigo. Las acusaciones por, supuestamente, no haber defendido al presidente con la vehemencia que él hubiera querido, fueron mensajes inequívocos de lo que un grupo de Morena y el círculo cercano a López Obrador, esperan de ella.
que la presidenta llegará sola, maniatada y sin fuerza para imponer sus convicciones, su criterio y sus prioridades al rumbo del país. Ella asumirá el cargo con una serie de instrumentos y apoyos sin referente en los más de 200 años de historia. Además, sus aliados como presidenta son muchos y de gran peso.
Sheinbaum llega con el respaldo de 36 millones de votos. Nunca un presidente había sido tan votado y eso es legitimidad pura. Tiene la mayoría parlamentaria, calificada, en ambas cámaras. Cuenta, si quiere tenerlo, con el apoyo institucional de los dos coordinadores parlamentarios de esas mayorías: Ricardo Monreal y Adán Augusto López. Muchos los consideran operadores de López Obrador impuestos a Sheinbaum, pero olvidan que los dos son damnificados políticos del presidente tabasqueño.
Director editorial de ejecentral, periodista, abogado y profesor en la UNAM. Ha dirigido la revista CAMBIO, Radio Capital, The News, Estadio, Rumbo de México y Capital, además de fundar el canal Greentv. Comentarista en medios, columnista político y autor de los libros Cien nombres de la Transición Mexicana, Chimalhuacán, el Imperio de La Loba, Chimalhuacán, Ciudad Perdida a Municipio Modelo y Huitzilan de Serdán, la derrota de los caciques
La actitud del presidente, decidido a no ceder un centímetro mientras su sexenio no haya terminado, empeñado en imponerle colaboradores, determinado a marcar la ruta del próximo sexenio, disfrutando hacerse acompañar de ella en su gira del adiós, cuando debería dejarla trabajar en la preparación del arranque de su gobierno, tampoco ha ayudado a conocer perfil, prioridades y proyecto de Sheinbaum.
Sin embargo, se equivocan quienes piensan
Monreal ha sido objeto de todo tipo de desprecios y malos tratos a lo largo del sexenio; el último fue operar para revertir la anulación de la elección en la alcaldía Cuauhtémoc, en perjuicio de su hija. Adán Augusto López, el llamado hermano, carga con el agravio de haber sido sacado del gobierno de Tabasco para colocarlo en Gobernación con la promesa de hacerlo candidato presidencial, pero al final fue colocado debajo de Gerardo Fernández Noroña en el resultado de la “encuesta” de Morena. Tiene una senaduría, pero es mucho menos de lo prometido. Tanto Monreal como Adán Augusto son priistas de formación. En su ADN político está la lealtad a la figura e institución presidenciales. Lo han sido y lo serán a López Obrador mientras la encarne, para luego ser igual de leales con Claudia Sheinbaum en cuanto tome posesión.
Lo mismo puede decirse de Marcelo Ebrard y de Juan Ramón de la Fuente. El primero tiene un doble agravio: cedió su lugar a AMLO cuando era el candidato más fuerte en 2006 y cuando era su turno, fue maltratado en el proceso interno morenista cuya equidad cuestionó. De la Fuente trató de ser canciller en el último año del gobierno lopezobradorista y fue despreciado por el mandatario. Eso lo llevó a dejar la representación de México ante la ONU y sumarse al proyecto de Sheinbaum. Muchos gobernadores morenistas comparten el ADN político priista, Son leales a la figura e institución presidenciales, más que a un caudillo. La presidenta tiene de su lado, además, otra institución fundamental: las fuerzas armadas de las que será comandante suprema desde mañana. Claudia Sheinbaum tendrá de su lado a los científicos, académicos y estudiosos universitarios. La consideran una de ellos y esperan su refrendo al conocimiento, a la libertad de cátedra y a la autonomía de las universidades. Por si todos esos aliados y respaldos institucionales no fuera suficiente, la Presidenta tendrá de su lado, desde que tome posesión, a toda la sociedad civil que no votó por ella el 2 de junio pasado, pero que ve en su llegada una esperanza sólida de terminar con la polarización y confrontación maniquea, que además está en contra de todo lo que suene a maximato o dinastía hereditaria. El expresidente Ernesto Zedillo lo dijo con mucha claridad en su entrevista con Ciro Gómez Leyva: la doctora Sheinbaum tiene la capacidad de ver la disyuntiva y entender la decisión que deberá tomar. En definitiva, Claudia Sheinbaum no llega sola ni carente de poder. Al contrario.

Cada que en Estados Unidos se celebra el Mes de la Herencia Hispana, mucho se discute en los medios y la academia sobre la manera en que la tendencia mainstream, es decir la convencional o tradicional, debería de denominar a los latinos o hispanos en ese país.
El tema en realidad se debate más entre las comunidades que no son de origen latino, pues para este segmento, que suma más de 65 millones de personas, el llamarse de tal o cual forma es un ejercicio más bien inútil que, en el mejor de los casos, sólo sirve para fines estadísticos.
Y en el peor de los casos, sin embargo, sirve para encasillamientos o para conferir etiquetas que no ayudan en otros planos, como el de la movilidad social, por ejemplo.
En años recientes, sobre todo desde cuando se comenzó a darle relevancia a aspectos como el lenguaje inclusivo, se instaló —o se quiso imponer, pues— una serie de términos para definir o llamar a las personas de origen latino e hispano en Estados Unidos.
De ahí surgieron etiquetas como “latinx”, o “hispanix” y, en determinados círculos “latine”.
Esta práctica de ubicar a las personas en determinados segmentos demográficos surgió en parte por necesidades de estadística y diversidad. Es decir, como el consenso maniqueo consistía en que los estadounidenses ubicaban a su universo poblacional en un espectro sin medias
tintas, sólo existía, a la hora de pensar en registros, en blancos y negros.
Para comunidades conscientes de su origen, esto entrañaba un dilema pues, a la hora de llenar un formulario oficial, las únicas opciones eran: blanco o negro.
Luego, esa canasta se amplió y con las minucias del lenguaje se podía elegir entre blanco, afroamericano, asiático americano, indígena nativo hasta hispano o latino. En este último caso, brincaba cierta justicia poética ya que se incluía —e incluye, a la fecha— una nota que refiere que los hispanos o latinos pueden ser de cualquier raza.
Así que si una persona de origen latino que llena un formulario oficial en Estados Unidos quiere poner su origen étnico (que hasta eso, es un acto voluntario), puede poner “Hispanic”, aún si entre su crisol incluye un abuelo chino, una abuela japonesa, un papá indígena y una mamá mestiza o europea… o cualquier combinación que se les ocurra. Si esta persona es originaria de Perú o México o Colombia, puede elegir esa casilla.
Pero como decíamos al inicio, desde hace algunos años hay algunos grupos que empujan la idea de que “Latino” o “Hispanic” no reflejan inclusividad o pertenencia total.
Ahora bien, ¿qué piensan los involucrados en esto; es decir, las personas de origen latino o hispano en Estados Unidos? Como decimos en México, en realidad les vale gorro. O, por lo menos,
la inmensa mayoría no apoya esa tendencia de que un término como “latinx” los defina. Eso es lo que concluye en un reporte el Pew Research Center.
Derivado de un sondeo aplicado a personas de origen latino e hispano, el Pew refiere que aunque tres terceras partes de las personas de este grupo demográfico han escuchado el término “latinx”, sólo 4% lo ha utilizado en determinadas ocasiones para describirse.
El Pew concluye que aunque el término lo usan celebridades, líderes de opinión, medios y académicos, en realidad no ha prendido entre la población en general.
¿Cómo prefieren que se les llame (sin meterse a detalles en cuanto a pensar en mexicoamericanos, colomboamericanos, etc)? “Si bien el conocimiento del término ha crecido, la proporción que usa “latinx” para describirse a sí mismos se mantiene (baja): el 4% de los adultos latinos dicen que han usado ”latinx” para describirse a sí mismos, pero poco cambiado desde el 3% que dijo lo mismo en 2019”. Esto ha llevado a muchas entidades, organizaciones, universidades y otros grupos, a declarar que ya no utilizarán el término para referirse a los latinos e hispanos, sin importar si “latinx” es promovido por quienes proponen un uso inclusivo o “gender-neutral”.
: LA NUEVA DIRIGENCIA del partido, liderada por Luisa María Alcalde, gestionará dos mil 446 millones de pesos en un año sin elecciones federales ni de gubernaturas
TANIA ROSAS redaccion@ejecentral.com.mx
La nueva dirigencia de Morena, encabezada por Luisa María Alcalde, tendrá acceso a dos mil446 millones de pesos en 2025, según los cálculos preliminares del Instituto Nacional Electoral (INE). Este presupuesto histórico marca un hito para el partido político en un año sin comicios federales ni renovaciones de gubernaturas.
El poder económico de Morena se deriva de la votación obtenida en las elecciones para diputados federales del pasado 2 de junio. Cuantos más votos consigan los partidos en estas elecciones, mayor será el financiamiento recibido en los próximos tres años.
Morena logró 40.84% de la votación, equivalentes a 24.2 millones de votos, una cifra sin precedentes en su década de historia. En 2021, la cifra fue de 16.7 millones (34.09%) y en 2018, de 20.9 millones (37.25%).
El INE ha aprobado un financiamiento público total de siete mil 354 millones de pesos para los seis partidos políticos con registro nacional en 2025. De esta suma, dos mil 446 millones serán destinados a Morena para actividades ordinarias, específicas y franquicias postales y telegráficas. Para las actividades ordinarias permanentes, el INE destinará siete mil tres millones 402 mil 870 pesos. El 30% de esta cantidad se distribuirá equitativamente entre los partidos, mientras que 70% restante se asignará en función del porcentaje de votos obtenidos en las elecciones a diputados federales. La misma fórmula se aplicará para las actividades específicas, que ascenderán a 210 millones 102 mil 86 pesos en 2025.
Así, al partido guinda le corresponderían dos mil 352 millones de pesos para actividades ordinarias, 70.5 millones para actividades específicas, 23.3 millones como franquicia postal y 115 mil 582 pesos como franquicia telegráfica.
Morena recibiría más del doble de recursos que el PAN, el segundo partido con más votos en la elección de diputados federales, que alcanzó 10 millones de votos (16.89%).
Este año, marcado por las elecciones más grandes en México, Morena contó con un presupuesto de 3,168 millones de pesos, de los cuales dos mil 46 millones fueron
DE ACUERDO con cifras preliminares, Morena será el partido que más recursos públicos, por prerrogativa, haya recibido en la historia de México. Se le asignarían de la siguiente forma:
$70,569,088 Actividades específicas
$23,344,676 Franquicia postal $115,582 Franquicia telegráfica

Morena se posiciona para gestionar un presupuesto histórico, al consolidar su poder económico y político en un año clave para el partido.
destinados al sostenimiento de actividades ordinarias permanentes.
En el Congreso de la Unión, se esperan iniciativas que propongan reducir el financiamiento público a los partidos políticos, un esfuerzo que se ha intentado en al menos dos legislaturas anteriores sin éxito.
$2,352,302,955
Actividades ordinarias permanentes
LA VOTACIÓN en las elecciones a diputados federales determina los recursos que se asignan a los partidos políticos.
Fuente: INE EL PRESUPUESTO DE LOS AÑOS ELECTORALES
Una nueva dirigencia con poder económico y político
A partir del 1 de octubre, el partido fundado por Andrés Manuel López Obrador será dirigido por tres figuras clave: Luisa María Alcalde, exsecretaria de Gobernación; Carolina Rangel, exsecretaria de Igualdad Sustantiva y Desarrollo de las Mujeres en Michoacán; y Andrés Manuel López Beltrán, hijo del presidente saliente.
Alcalde, al frente del partido más grande de México y en el poder, no sólo deberá fortalecer la estructura interna, sino también evitar fracturas entre las evidentes corrientes encabezadas por López Obrador, Claudia Sheinbaum, Ricardo Monreal, Adán Augusto López y Marcelo Ebrard.
López Beltrán, a pesar de los señalamientos en su contra por presuntos actos de corrupción, será responsable de mantener la comunicación con los comités municipales, coordinar las afiliaciones y supervisar la acción electoral del partido en todos sus niveles.
Esta nueva generación de líderes llega en un momento de considerable poder económico y político. Morena y sus aliados gobiernan en 23 entidades, 13 de 29 capitales y en las principales ciudades del país, según un análisis interno realizado por Mario Delgado.
“El número de personas gobernadas por Morena a nivel nacional aumentó de 35 millones en 2018 a 94 millones en 2024”, destaca el dossier. Además, resalta el crecimiento en la representación legislativa: de 191 diputados (38.2%) en 2018, a 248 en la actualidad, consolidándose como la mayoría simple con 253 diputados (60.6%).
“Bajo la dirigencia de Mario Delgado, Morena ha participado en 32 procesos electorales estatales, obteniendo la victoria en 24 gubernaturas. En 2024, se destaca la victoria en siete de las nueve gubernaturas en juego, así como la obtención de la mayoría calificada en la Cámara de Diputados, junto a sus aliados del PVEM y PT”, agrega el documento.
El equipo de Alcalde, Rangel y Andy López Beltrán demostrará su influencia en 2027, durante las elecciones intermedias que renovarán la Cámara de Diputados y 15 gubernaturas. Esta dirigencia será responsable de seleccionar a los candidatos.
Sin embargo, será una etapa marcada por la ausencia de la fuerza lopezobradorista, ya que Andrés Manuel López Obrador, al menos en sus declaraciones, planea retirarse de la política, dejando a su hijo Andy como heredero de su legado. En 2027, además, un Presidente de la República enfrentará de nuevo un proceso de revocación de mandato, que en este caso corresponderá a Claudia Sheinbaum. Durante la revocación de mandato de López Obrador, Morena jugó un papel crucial en la difusión de su imagen, aunque los números no fueron suficientes para que la consulta resultara vinculante.

Juan de Dios Vázquez

Hoy finaliza la administración de Andrés Manuel López Obrador, marcando un punto de inflexión en la historia contemporánea de México. Tras seis años al frente de la presidencia, su partida deja un vacío que no sólo se siente en su partido, Morena, sino en el país entero. López Obrador, una figura omnipresente en la política mexicana, ha construido un legado que trasciende sus acciones de gobierno. Sin embargo, más allá de sus logros o controversias, lo que verdaderamente inquieta es el rol que jugará su ausencia. México parece encaminarse a una etapa de “duelo”, donde el exmandatario seguirá estando presente simbólicamente, pero ausente en la realidad del poder político directo.
proyecto político y las estructuras que AMLO construyó, la sombra del expresidente seguirá proyectándose sobre su administración. Su éxito dependerá de su capacidad para seguir el proyecto de la 4T, pero imprimiéndole un carácter propio, donde sus convicciones y experiencia dejen una marca personal.
Juan de Dios Vázquez es doctor por la Universidad de Harvard y ganador del premio nacional del Comité Mexicano de Ciencias Históricas (2013). Ha sido Ministro en la Embajada de México en Estados Unidos, representante de México ante la Organización Mundial de Aduanas y Jefe de Oficina del Secretario de Seguridad y Protección Ciudadana.
Este duelo no es sólo político; es también simbólico, lo que nos lleva a analizar su figura desde una perspectiva psicoanalítica, concretamente a través de las teorías de Sigmund Freud y Jacques Lacan sobre el padre. En su ausencia, ¿qué papel jugará Claudia Sheinbaum, su sucesora en el liderazgo político? Y, más interesante aún, ¿cómo se inserta su hijo, Andrés López Beltrán, en esta narrativa, al asumir un rol clave dentro de la estructura del partido?
Para Freud, el padre es una figura central en el desarrollo psíquico del individuo, siendo el protagonista del famoso complejo de Edipo. En Tótem y tabú, Freud señala que el padre cumple una doble función: es protector y legislador, pero también es la figura que impone la prohibición, especialmente en términos de deseo y poder. Lacan retoma y amplía esta idea en su seminario Las psicosis, donde introduce el concepto del “Nombre-del-Padre” (Nom-du-Père). Este concepto se refiere a la función simbólica del padre no tanto como una figura real, sino como un lugar en la estructura psíquica y social. Para Lacan, el “Nombre-del-Padre” es la ley que regula el deseo y que, a
su vez, permite al sujeto integrarse en el orden simbólico, es decir, en la cultura y la sociedad.
Lacan juega con la homofonía entre “nom du père” (nombre del padre) y “non du père” (no del padre), destacando la función legislativa y prohibitiva del padre simbólico. Este padre es el que introduce el “no” que organiza y estructura el deseo, marcando las prohibiciones fundamentales. En términos políticos, podríamos entender a López Obrador como ese “Nombre-del-Padre” que establece los límites y define las coordenadas del nuevo México que él, en gran medida, ha contribuido a formar.
Con la llegada de Sheinbaum a la presidencia, muchos se preguntan si su liderazgo será capaz de llenar el vacío simbólico que deja López Obrador. Sheinbaum ha sido durante mucho tiempo una figura cercana a AMLO, tanto ideológica como políticamente. Sin embargo, el desafío de ocupar su lugar no es sencillo. Desde una perspectiva lacaniana, Sheinbaum podría verse destinada a asumir el rol del “Nombre-del-Padre”, pero siempre enfrentará la dificultad de no ser el original. Aunque puede continuar con el
El caso de Andy como el recién nombrado director de estructura de Morena es igualmente interesante. Su papel será crucial en mantener la cohesión y el rumbo del partido. Sin embargo, también enfrenta el desafío de ser el hijo del líder, una posición que Lacan describiría como problemática en el sentido de que el hijo siempre está a la sombra del padre. El “Nombre-del-Padre” no solo regula el deseo, sino que también genera una herencia simbólica que los hijos deben negociar, ya sea para aceptarla o para rebelarse contra ella.
México, como una familia que ha perdido al padre, experimentará un duelo tras la salida de López Obrador. No obstante, este duelo no implica únicamente tristeza, sino una reorganización simbólica y política. Lacan sostiene que la ausencia del padre no elimina su influencia. Al contrario, su ausencia puede reforzar su presencia en el plano simbólico. En este sentido, AMLO podría convertirse en una especie de tótem político del la 4T al que se recurrirá no solo para rememorar su legado, sino también para buscar orientación en momentos de incertidumbre.
Si seguimos la lógica de Lacan, la ausencia o exclusión del “Nombre-del-Padre” puede llevar a lo que él llama la “forclusión”, que se manifiesta en la psicosis. En términos sociales y políticos, esto podría significar que, sin una figura paterna clara, ya sea Sheinbaum o López Beltrán, México podría enfrentar una suerte de crisis de identidad política. La falta de un “padre” simbólico que ordene y regule el deseo colectivo podría llevar a un caos político, donde las estructuras que hasta ahora habían sido estables empiecen a fragmentarse poco a poco. Bajo estas líneas, es importante señalar que Lacan también ofrece una salida a esta psicosis. La figura del padre no tiene que ser necesariamente una persona en particular, sino que puede ser una estructura simbólica que organice el deseo. En este sentido, el reto para Morena y para México será construir una nueva narrativa y proyecto dentro de la 4T en la que el legado de AMLO esté presente, pero que no dependa exclusivamente de su figura personal.
El fin de la administración de López Obrador marca el cierre de un ciclo político y el inicio de una nueva etapa para México. Pero su influencia no desaparecerá con su partida. Como el “Nombre-del-Padre” en la teoría lacaniana, AMLO seguirá siendo una figura central en la configuración del deseo y la identidad política de la nación. Claudia Sheinbaum y Andrés López Beltrán enfrentarán el desafío de llenar ese vacío, pero también tendrán la oportunidad de redefinir lo que significa el liderazgo en un México post-AMLO. Al final, el legado del expresidente no sólo estará en lo que hizo o no hizo, sino en cómo su ausencia será interpretada y gestionada por aquellos que vienen después de él.
Desde la teoría lacaniana, el paso de López Obrador de “padre real” a “padre simbólico” es clave. Mientras el “padre real” ejerce el poder de manera práctica, el “padre simbólico” se transforma en una figura de referencia que regula el deseo y las leyes, incluso en su ausencia. Es posible que, a pesar de su retiro a Palenque y de su renuncia a Morena, siga influyendo en el rumbo del partido y del país, manteniéndose como un eje central en la configuración del deseo político de la nación.

Dolia Estévez
@DoliaEstevez
El insólito oprobio a la corona española y la raquítica lista de líderes con asistencia confirmada a la investidura de Claudia Sheinbaum retratan el aislamiento de México en el mundo y el quiebre con naciones hermanas. Faltando una semana para el traspaso de poderes, Sheinbaum decidió no invitar al rey Felipe VI, sin importarle que la Constitución española reserva al monarca la más alta representación del Estado en el ámbito internacional. El primer ministro español llamó “inaceptable” la exclusión del rey y rechazó participar a ningún nivel. El agravio fue el último capítulo en la crisis política sexenal que provocó el presidente López Obrador en 2019, cuando demandó al rey, que goza de alta popularidad en su país, disculparse por la Conquista. En lugar de comenzar con el pie derecho, Sheinbaum hizo suyo el pleito que justificó alegando que Felipe VI no respondió la petición de perdón.
Periodista de larga trayectoria en Washington, D.C. Corresponsal de diversos medios. Desde las entrañas del poder mundial, testigo de primera fila de hechos e hitos históricos que unen el destino de estos dos países.
Uno esperaría que la investidura de la primera mujer presidenta en Norteamérica despertara el ánimo y el entusiasmo de los gobiernos de las grandes y pequeñas democracias del mundo, pero no fue así. Solo 16 jefes de Estado y de Gobierno habían aceptado participar a mediados de mes. Trece de Latinoamérica y del Caribe, y tres de África. Ninguno de peso y ningún europeo. Estados Unidos y Canadá, nuestros vecinos y socios más importantes, serán representados por Jill Biden, la primera dama, un gesto más de amistad que de carácter oficial, y por la viceprimera ministra canadiense.
Y es que para muchas mexicanas –la autora de estas líneas incluida–, haber alcanzado la cúspide del poder más por el sometimiento a los dictados de un hombre autoritario que por otra cosa, eclipsa el hito histórico de ser la primera mujer presidenta de México. A este desanimo se suman claras señales de que la nueva presidenta seguirá la política exterior de su mentor sin aparente margen de autonomía. Sheinbaum informó recientemente que hará muy pocos viajes al extranjero porque su tarea principal es gobernar México como si se contrapusieran; lo mismo que López Obrador. Consecuentemente, rechazó la invitación del presidente de Ucrania para visitar el país invadido por Rusia bajo el pretexto de la “neutralidad”; igual que Andrés Manuel. Incumplió el tradicional simbolismo de conceder sus dos primeras reuniones diplomáticas como presidenta electa a los líderes de nuestros vecinos, Estados Unidos y Canadá; lo mismo que López. “El presidente y yo no somos la misma persona”, aclaró defensiva.
Diplomáticos esperanzados en un golpe de timón me dicen que el perfil de un canciller muy cercano a ella, que ha mostrado sensatez en momentos clave, pudiera llevar a pensar que sí habrá cosas que se lleven a cabo de manera diferente. Pese a su escasa experiencia diplomática, Juan Ramón de la Fuente emanó buena vibra con sus votos de condena a la invasión rusa de Ucrania al inicio de la guerra de conquista cuando fue representante en la ONU. Sin embargo, la injustificada invitación a la investidura de Sheinbaum del dictador
ruso que sigue masacrando a civiles y secuestrando a niños de ese país, indica que su influencia sobre ella es limitada o que coincide plenamente con el manejo ideologizado e ignorante de la diplomacia de López. Hasta ahora Sheinbaum no ha hecho designaciones en el extranjero que puedan delinear un perfil de continuidad o de cambio. No se sabe si nombrará a diplomáticos de carrera, políticos corruptos a quienes le debe favores o ineptos militantes partidistas que responden a Morena, no al Estado. Botón de muestra son el video viralizado de la cónsul en Estambul amenazando enojada con suspender el Grito y el cónsul morenista de Denver lambisconeando a la próxima presidenta. Ambos violaron el Artículo 41 de la Ley del Servicio Exterior que prohíbe el partidismo en las representaciones diplomáticas. “Para el SEM vienen más años flacos, flaquísimos y el efecto acumulado será devastador”, me dijo un diplomático de carrera.
Queda esperar que el nuevo gobierno recupere la tradición de nuestra política exterior, retorne al poder moral de creer en el derecho internacional, en las instituciones multilaterales, en las relaciones diplomáticas cordiales y de respeto, en el fortalecimiento de alianzas y amistades, y reviva la visión humanista de solidaridad con los pueblos violados por ejércitos invasores y oprimidos por dictadores regionales. En resumen, esperar que la primera presidenta mujer sea una buena gobernante que honre su responsabilidad con México y el mundo sin ataduras machistas.

TEXTO Y CONTEXTO

Se va AMLO, pero ¿realmente se va?
Amedida que se acercaba el final del sexenio de Andrés Manuel López Obrador (AMLO), el debate sobre su legado se intensificó. Si bien algunos aplaudieron sus políticas sociales, otros cuestionaron su enfoque en el “combate” a la corrupción y señalaron con preocupación la erosión de la democracia y las instituciones en México. La crítica y el señalamiento constante a los medios de comunicación y a los periodistas que dieron cuenta de las fallas durante su gobierno alimentaron un ambiente de división y desconfianza durante su administración.
delito, además de despertar dudas y conflictos económicos en la relación con otros países.
En este contexto, llega Claudia Sheinbaum a la presidencia del país, enfrentando un reto monumental: diferenciarse de AMLO y construir una narrativa propia que inspire confianza en toda la ciudadanía y en el exterior como lo ofreció en su discurso la noche del 2 de junio: “concebimos un México plural, diverso y democrático… nuestro deber será velar por cada una y cada uno de los mexicanos sin distingos”.
Periodista con 28 años de experiencia. Ganador del Premio Nacional de Periodismo. Conductor del noticiero meridiano en UNOTV y asesor en medios de comunicación. Ha trabajado en Televisa y Grupo Imagen; también fue colaborador en Más por Más Excélsior y Newsweek. Autor de El Caso Florence Cassez, mi testimonio
La inseguridad y la violencia son otras áreas donde el gobierno se va en números rojos. A pesar de las múltiples promesas de pacificación, la violencia ha aumentado en diversas regiones. Michoacán, Chiapas, Guerrero y Morelos son ejemplo de ello. Este año electoral por ejemplo, se agudizó la inseguridad. Treinta aspirantes, entre precandidatos y candidatos fueron asesinados durante las campañas.
La militarización de la seguridad pública, centrada en el uso de las Fuerzas Armadas, ha generado serios cuestionamientos sobre el respeto a los derechos humanos y la falta de una verdadera política de prevención del
Sin embargo, la ironía se vuelve palpable cuando ella misma dice que el presidente “se va y al mismo tiempo no se va”, cuando en los momentos cruciales de las últimas semanas, ante reformas, toma de decisiones y el aumento de la violencia, no hemos visto un llamado claro a fomentar el diálogo y la inclusión.
Lo que sí ha declarado la próxima presidenta de México es que: “La continuidad va a existir; es un mismo proyecto; continuidad con mi estilo, con mi proyecto, pero continuidad en la Cuarta Transformación.”
Continuidad que la llevó a revivir, sin necesidad alguna, en un momento que debería ser de celebración para ella, un conflicto diplomático con España generado por el
presidente Andrés Manuel Lopez Obrador en 2019 al no recibir respuesta del Rey Felipe VI a la carta en la que le pedía ofreciera una disculpa a los mexicanos por los excesos cometidos durante la colonización española. El legado del presidente va más allá de una lista de políticas sociales y obras públicas que aún no muestran su valor. Se trata de un contexto hostil y violento, marcado por rencores, venganzas y la división social, que ha moldeado la percepción pública sobre la política mexicana. Claudia Sheinbaum tiene la oportunidad hoy de transformar este panorama, demostrando que la política puede y debe ser un espacio de respeto, diálogo y verdadero servicio a la ciudadanía.
Para lograrlo, no basta con ser la primera mujer presidenta de México; debe convertirse en una líder que establezca su propia voz y personalidad, que desafíe las narrativas simplistas y que trabaje por un país más democrático y seguro para todas y todos, donde cada ciudadano sienta que su voz importa. Este es el verdadero desafío que enfrenta la nueva presidencia: construir un futuro donde la confianza y la inclusión sean la norma, no la excepción.
¿Podrá? ¿Querrá? Veremos.

Reforma indígena y afromexicana:
¿un paso hacia la justicia?
Julieta Mendoza
México tiene una deuda histórica con los pueblos indígenas y afromexicanos. Desde la época colonial, estas comunidades han sido excluidas, marginadas y discriminadas.
En un intento por corregir este legado de injusticias, el Congreso Federal aprobó recientemente una reforma que, por primera vez, reconoce a los pueblos indígenas y afromexicanos como sujetos de derecho público, dotándolos de personalidad jurídica y patrimonio propio.
El primer reconocimiento oficial hacia los pueblos indígenas en México ocurrió en 1992, durante el gobierno de Carlos Salinas de Gortari. Ese año se reformó el Artículo 4 de la Constitución, estableciendo a la nación mexicana como pluricultural, basada en la existencia de sus pueblos indígenas. Aunque este cambio representó un avance simbólico importante, fue limitado. No incluyó derechos específicos ni garantizó la autonomía o la autodeterminación de las comunidades indígenas. En ese sentido, la reforma fue más declarativa que sustancial, dejando sin resolver muchas de las demandas históricas de estas comunidades.
El reconocimiento se profundizó en 2001, en respuesta a las demandas del Ejército Zapatista de Liberación Nacional (EZLN), después del levantamiento de 1994 en Chiapas.
que habían sido ignoradas por completo en la legislación, no recibieron reconocimiento constitucional hasta 2019. Si bien este reconocimiento fue un paso importante, sigue siendo insuficiente para resolver las demandas de justicia, inclusión y representación que estas poblaciones han reclamado durante décadas.
La nueva reforma constitucional, aprobada en el Congreso Federal en el gobierno de López Obrador, marca un avance significativo al otorgar reconocimiento pleno a los derechos de más de 23 millones de indígenas o afrodescendientes.
Otro de los puntos relevantes de la reforma es el reconocimiento de su derecho a la autonomía y autodeterminación, lo que permitirá a los pueblos organizar su vida social, política, económica y cultural conforme a sus propias costumbres y tradiciones. Ejercer estos derechos implicará el control directo sobre sus territorios y recursos, otorgándoles opinión y actuación en las decisiones que impactan su vida y sus hábitos sociales.
El desarrollo de grandes proyectos mineros o energéticos en tierras indígenas ha sido un foco de conflicto durante décadas, y la vigencia jurídica de derechos como la consulta previa podrían generar tensiones entre las comunidades y los actores económicos. Ahí debe entrar la espada de la justicia. Además, existe la resistencia de algunos gobiernos estatales, acostumbrados a ejercer un control sobre los territorios indígenas. Esta resistencia puede dificultar que la reforma tenga un impacto real y profundo, ya que muchos de estos gobiernos podrían intentar minimizar o bloquear los derechos recién adquiridos por las comunidades. Otro obstáculo es la falta de infraestructura institucional y política para garantizar que los derechos consagrados en la reforma sean respetados y aplicados en la práctica. Las comunidades indígenas y afromexicanas no solo necesitan reconocimiento legal, sino también recursos y apoyo institucional que les permitan ejercer sus derechos de manera efectiva.
Comunicadora con más de 20 años de experiencia como conductora, reportera y comentarista. Combina su trabajo en medios con la docencia y la asesoría en voz e imagen para profesionales.
La reforma al Artículo 2 de la Constitución introdujo el reconocimiento de los derechos de los pueblos indígenas a la libre determinación, a la autonomía y a la preservación de sus lenguas, culturas y sistemas normativos. Pero muchas de las demandas de los pueblos originarios como la consulta previa, el control sobre su territorio y una verdadera autonomía, quedaron insatisfechas.
Por su parte, las comunidades afromexicanas,
Este paso es crucial para transformar las estructuras de poder entre el Estado y los pueblos originarios, y para avanzar hacia una relación justa y equitativa. Las comunidades indígenas y afromexicanas podrán participar activamente en decisiones que antes se tomaban sin su consulta, muchas veces afectando gravemente sus territorios y formas de vida, especialmente en áreas como la minería y proyectos con alto impacto ecológico. No obstante, aunque estas modificaciones representan un avance considerable, su aplicación enfrenta serios desafíos. Entre ellos la resistencia de ciertos sectores políticos y empresariales que perciben estos cambios como una amenaza a sus intereses económicos, particularmente en regiones ricas en recursos naturales.
Sin el respaldo del Estado para implementar políticas públicas específicas y proveer los recursos necesarios, se corre el riesgo es que la reforma quede como una declaración de intenciones sin consecuencias reales.
La reforma constitucional indígena y afromexicana no es sólo una cuestión de derechos legales; es una batalla por el reconocimiento de la dignidad e identidad de pueblos históricamente invisibilizados. Su aprobación es un paso significativo hacia una sociedad más inclusiva y plural, pero el éxito de la reforma dependerá de su implementación efectiva. ¿Será esta reforma el inicio de una nueva era de justicia social en México, o se quedará como otro documento lleno de promesas incumplidas? Solo el tiempo y la acción política lo dirán.


Sergio Uzeta
Periodista con más de tres décadas de experiencia, exdirector de Notimex y fundador del Canal Judicial, con trayectoria en Pemex y la Presidencia. Ha sido galardonado con el Premio Nacional de Periodismo. EN PERSPECTIVA
Claudia Sheinbaum asume la Presidencia de México, marcando un hito histórico como la primera mujer en ocupar el máximo cargo del país. Sin embargo, aunque este hecho es motivo de celebración y representa un avance en términos de equidad, no basta con su género para garantizar los cambios profundos que México necesita. Gobernar un país complejo y dividido como el nuestro requerirá mucho más que un enfoque basado en el género.
En los últimos meses de transición, quedó claro que Sheinbaum no sólo tendrá que lidiar con los retos de la administración pública, sino también con la influencia persistente de Andrés Manuel López Obrador, su predecesor y mentor político.
Los roces que surgieron entre la casa de transición y Palacio Nacional, especialmente en torno a la designación del nuevo gabinete y la implementación de la reforma judicial, revelan que la presidenta Sheinbaum tendrá que esforzarse mucho para ejercer su propio poder y definir su propio estilo de gobierno
La expectativa de que, por ser mujer, ella tendrá una mayor sensibilidad y respeto hacia los derechos de ciertos grupos
históricamente marginados es simplista. Aunque las mujeres han ocupado cada vez más posiciones de poder en todo el mundo, esto no asegura que automáticamente habrá una transformación en la forma de gobernar. Sheinbaum deberá probar que puede ir más allá del género y ofrecer soluciones concretas para los problemas más urgentes del país. ›La administración de López Obrador, a pesar de algunos logros, ha dejado heridas abiertas en varios sectores de la sociedad. La polarización política, el incremento de la violencia y la percepción de impunidad son algunos de los desafíos que la nueva Presidenta hereda.
Su éxito no dependerá de ser la primera Presidenta mujer, sino de su capacidad para distanciarse de las políticas que han generado divisiones y ejercer el poder de manera efectiva para el bien común.
Lo que está en juego no es sólo la transición de una Presidencia masculina a una femenina, sino la capacidad de Sheinbaum para generar un cambio real. La historia ha
demostrado que el género no es un factor determinante en la calidad de un gobierno. Lo que se necesita es liderazgo, capacidad de decisión y una visión clara de hacia dónde debe ir el país. Claudia Sheinbaum tiene ante sí la oportunidad de demostrar que puede ser la Presidenta de todos los mexicanos, no sólo de los que votaron por ella o pertenecen a Morena. Si bien ser mujer puede aportar una perspectiva distinta, no será suficiente para resolver los problemas estructurales del país. Lo que realmente importará será su capacidad para ejercer el poder de manera efectiva, su habilidad para distanciarse cuando sea necesario de las políticas de su predecesor y, sobre todo, su compromiso con todos los mexicanos, independientemente de su afiliación política.
La Presidencia de Claudia Sheinbaum representa una nueva etapa en la política mexicana, pero no debe verse únicamente a través del prisma del género. Su legado dependerá de su habilidad para sanar las divisiones del país, reducir la violencia y crear un gobierno inclusivo que respete los derechos de todos. Ella tiene que demostrar que el verdadero cambio no viene por el hecho de ser mujer, sino por la capacidad de gobernar con sensibilidad, justicia y humanidad.

Inteligencia artificial y propiedad intelectual: el desafío de nuestros tiempos
Santiago Nieto Castillo
@SNietoCastillo
Abogado. Profesor universitario. Especialista en materia electoral, PLD, combate a la corrupción y procuración de justicia.
La inteligencia artificial (IA) ha transformado múltiples sectores, desde la atención médica hasta la educación y el entretenimiento. A medida que esta tecnología avanza, surgen importantes interrogantes sobre la propiedad intelectual (PI). La capacidad de la IA para crear, aprender y generar contenido plantea desafíos y oportunidades en el ámbito legal, ético y comercial. La propiedad intelectual se refiere a un conjunto de derechos legales que protegen las creaciones del intelecto humano.
›No obstante, algunos de los retos de la protección de la PI respecto a esta materia son, en torno a quién posee el contenido generado por la IA. Si una IA crea una obra original, ¿es el creador humano quien la programó, el usuario que la solicitó, o la propia IA? Esta ambigüedad ha llevado a debates sobre la necesidad de reformar las leyes de derechos de autor. Por otro lado, algunas jurisdicciones han
comenzado a considerar si las invenciones generadas por IA pueden ser patentadas. Sin embargo, la Oficina de Patentes y Marcas de Estados Unidos ha señalado que el inventor debe ser un ser humano, lo que limita la capacidad de proteger inventos creados enteramente por máquinas. El problema es qué humano. El que construye el sistema o el que ingresa la información?
Asimismo, la inteligencia artificial a menudo se entrena utilizando grandes conjuntos de datos que pueden incluir obras protegidas. Esto plantea preguntas sobre la legalidad del uso de tales datos sin el permiso de los titulares de derechos.
Ahora bien, también se presentan oportunidades en este campo para mejorar la gestión y protección de la propiedad intelectual como el apoyo de IA para detectar infracciones de propiedad intelectual en línea, facilitando la labor de monitoreo y protección de derechos; herramientas de IA pueden analizar bases de datos de patentes para ayudar a identificar tendencias e innovaciones; la posibilidad de personalizar contenido a través de IA podría llevar a nuevas formas de creación artística, ampliando las
oportunidades para los creadores.
A medida que la IA continúa evolucionando, la legislación sobre propiedad intelectual deberá adaptarse para abordar la complejidad de la creación asistida por máquinas. Esto incluye la reformulación de leyes de derechos de autor para reconocer el valor de las obras creadas por inteligencia artificial; una definición clara de la autoría y derechos de las invenciones generadas por IA, o el establecimiento de directrices sobre el uso ético y legal de los datos para el entrenamiento de modelos de IA.
El avance de la inteligencia artificial plantea un desafío único para la propiedad intelectual. A medida que la línea entre la creación humana y la generada por máquinas se difumina, es fundamental que legisladores, creadores, los diversos sectores y la comunidad científica colaboren en la construcción de un marco legal que proteja los derechos de todos los involucrados. México no será la excepción en atender y regular este enorme campo de innovación y el uso de nuevas tecnologías, y fortalecer por otro lado, el marco de protección a la propiedad intelectual donde la IA se aplique.

LA PREGUNTA INCÓMODA

¿Quién manda aquí?
José Ángel Santiago Ábrego
MPrimer Vicepresidente de la Asociación Nacional de Abogados de Empresa e integrante del Consejo General de la Abogacía Mexicana y socio de SAI, Derecho & Economía, especializado en litigio administrativo, competencia económica y sectores regulados.
añana toma protesta como presidenta de México Claudia Sheinbaum Pardo y, a partir de ese momento, habrá de comenzar a resolverse el dilema del poder. Un dilema que poco tiene que ver con los objetivos nominales a alcanzar (después de todo, el presidente saliente y la presidenta entrante son parte del mismo movimiento político) y más con los mecanismos que se plantean para alcanzarlos. En un primer escenario, la presidenta podría optar por darle continuidad a las formas de su antecesor, mantener intocadas las lealtades del régimen y tratar de que sus decisiones sean vistas con buenos ojos por el presidente saliente. En este contexto, cabría esperar no solo la aprobación de las iniciativas de reforma constitucional presentadas en febrero pasado (desaparición de órganos constitucionales autónomos, indexación del salario mínimo a la inflación, adscripción de la Guardia Nacional a la Secretaría de la Defensa, endurecimiento de la prisión preventiva, entre otras), sino que éstas y las nuevas que se presenten sean aprobadas sin escuchar las inquietudes de la sociedad y sin considerar las formalidades que rigen el procedimiento. Cabría esperar también un creciente desprecio y desacato hacia las órdenes emitidas por los jueces de amparo, bajo la confianza de que difícilmente las fiscalías (que son autónomas en el papel, pero no en los hechos)
perseguirán ese incumplimiento. Se anticiparía la constitucionalización del piso no parejo en favor de Pemex y CFE, sin importar que los privados hayan realizado inversiones bajo la confianza de que el Estado Mexicano sería estable en las reglas vigentes al momento de formular el plan de negocios correspondiente. Podríamos esperar que se siga legislando, regulando y aplicando la ley, al amparo de la premisa de que lo que importa es 90% lealtad y 10% capacidad.
Alternativamente, la presidenta podría optar por impulsar objetivos que, más que apuntar a la concentración de poder por sí misma, apunten al bien mayor del Estado Mexicano. Podría adoptar herramientas que sean sensatas, confiables, técnicas y respetuosas del Estado de Derecho, que partan del reconocimiento de que la realidad compleja no puede abordarse a partir de soluciones simplonas y sin rigor. En este escenario, podríamos esperar deliberación en el Congreso que incluya a todas las fuerzas políticas y que escuche las propuestas provenientes de todos los sectores de la sociedad, no sólo para dar la impresión de inclusión sino para allegarse de las mejores ideas en beneficio de los mexicanos (particularmente en la concreción de la Reforma Judicial, de tal manera que no se afecte irremediablemente la independencia e imparcialidad de los juzgadores, aspectos indispensables para que México
se mantenga competitivo). También anticiparíamos un mayor respeto a las instituciones, a los pesos y contrapesos y a las decisiones jurisdiccionales de todo tipo, que mande el mensaje de que México es un país confiable para hacer negocios. Cabría esperar que la presidenta, experta en la relación entre el cambio climático y la energía, otorgue un nuevo impulso a la generación eléctrica a partir de fuentes renovables y conceda su justa medida a los problemas ambientales asociados a los proyectos de infraestructura que hereda.
Conocer la solución del dilema es de la mayor trascendencia para las empresas. De eso dependerá la estrategia que habrán de adoptar para sus decisiones en los siguientes años. ¿Estrategia de mitigación de riesgos para la inversión, o estrategia para aprovechar las condiciones geopolíticas que hacen a México atractivo para hacer negocios? ¿Insertar o no en los planes de negocio un factor de riesgo asociado a la desprotección por la erosión en la función jurisdiccional? ¿Destinar más presupuesto a los equipos de cabildeo, bajo la premisa de que la arbitrariedad normativa y administrativa no podrá ser remediada en los tribunales? De ahí la relevancia y urgencia de saber, en realidad, quién manda aquí.
* Esta columna se hace en colaboración con María José Fernández Núñez
: A PESAR DE SER PREVENIBLE en casi todos los casos, en México mueren en promedio 13 mujeres al día debido a esta morbilidad
MANUEL LINO GONZÁLEZ mlino6@gmail.com
El cáncer cervical, usualmente provocado por el virus del papiloma, es prevenible en un 99.7%, y sin embargo, uno de cada 25 cánceres a nivel global es de este tipo; en la región latinoamericana se produce una muerte por cáncer cervical cada 15 minutos, y en México esto sucede en promedio cada hora con 48 minutos.
Debido a esta realidad, un equipo de expertas y expertos en salud pública y en este cáncer pide que se establezca un programa único para la prevención y control de este cáncer en México.
De acuerdo con cifras presentadas por Lucely del Carmen Cetina Pérez en el Seminario Latinoamericano de Periodismo en Ciencia y Salud, el cáncer cérvicouterino ocupa el segundo lugar en el país tanto en su incidencia, pues se registran 28 casos en promedio al día, como en mortalidad, pues cada día mueren en promedio 13 mujeres por esta causa.
La experta del Instituto Nacional de Cancerología señala que se detectan 28 casos al día de cáncer cérvicouterino, y que se han identificado 48.8 millones de mujeres de 15 a 44 años en riesgo de desarrollar este tipo de cáncer entre las que tienen. Esto sucede a pesar de que en los últimos años, la aplicación de la vacuna contra el virus del papiloma humano (VPH), que podría prevenir el 90% de los casos cáncer cervical, y la detección oportuna de los casos han reducido la incidencia de este problema de salud.
Entre 2000 y 2019, la tasa de mortalidad por cáncer en San Luis Potosí bajó casi cinco veces, de 22 a 4.6 muertes por cada 100 mil habitantes. Colima y Jalisco también mostraron avances significativos, con caídas de 3.3 y 3.1 veces, respectivamente.
Uno de los casos más notables es el de Nayarit, pues tenía la tasa de mortalidad más grande del país con 36.2 muertes por cada cien mil habitantes debidas al cáncer cervical, y en esas dos décadas se redujo 2.9 veces a una tasa de 12.6, esto implicó que se salvaran unas 23.5 vidas por cada cien mil habitantes.
Tanto la aplicación de la vacuna contra el VPH como la detección oportuna o tamizaje de las personas que ya han sido infectadas con el virus o están en las primeras fases del desarrollo del cáncer podrían mejorar mucho más en México.
Vacunación, con altas y bajas
En comparación con otras grandes economías de América Latina, en México tenemos en los últimos años uno de los peores desempeños de la región, después de haber registrado uno de los mejores. De acuerdo con las cifras de vacunación de la Organización Mundial de la Salud (OMS), México tuvo, por mucho, la peor cobertura de la dosis final a mujeres de vacuna contra el VPH durante los años de la pandemia, ya que después de haber reportado un 97% en 2019, al año siguiente bajó a 11% y en 2021 hasta 0.45%. En 2022 y 2023 se registró un aumento a 48.01% y 57.75%, respectivamente.
Un poco menos dramática fue la caída en la primera dosis de la vacuna, que normalmente se aplica antes de los 15 años, pues pasó de un reportado 99% en 2018, a 44% y 20% en los años siguientes y cayó 1% en 2021, la recuperación fue al 80% en 2022 y 62% en 2023. Los datos de la OMS también revelan que en los otros cinco países grandes de la región se aplica la vacuna a los varones, incluyendo a Colombia y a Perú, que empezaron en 2023; mientras que en México aún no se toma esta medida que puede prevenir el contagio y el desarrollo de cáncer en personas de sexo masculino.
El tamizaje, el otro filtro
La otra forma de prevenir las muertes por cáncer cervical es la detección oportuna o tamizaje, para lo cual existen dos pruebas: la citología cervical, comúnmente conocida

13.2 CASOS por cada 100 mil mujeres fue la incidencia del cáncer cervical en México en 2022, casi igual a la tasa global de 13.3
México enfrenta retos importantes… que en conjunto podrían encaminar a la eliminación del CC (cáncer cervical) como un problema de salud pública”.
Leith León-Maldonado et al, ENSANUT 2023.
como prueba de Papanicolaou y que puede detectar el cáncer en sus primeras etapas de desarrollo, y la detección del ADN del virus del papiloma, que la OMS recomienda como método preferente y que está disponible en México desde 2007. Según la recientemente publicada Encuesta Nacional de Salud y Nutrición de 2023 (Ensanut 2023), la realización de pruebas de detección en mujeres de 25 a 64 años también bajó en la pandemia, pues la prevalencia pasó de 34.6% para el Papanicolau y 12.7% para la detección de VPH en 2018, a 24.9% y 11%, respectivamente, en 2021. Para 2023 se recuperó la realización de pruebas, pues las prevalencias fueron de 31.5% para el Papanicolau y 16% para la del VPH, y la suma de ambas (47.5%) es ligeramente mayor a la de 2018 (47.3%); sin embargo, estas cifras superan por poco al dato anterior de la ENSANUT 2012, cuando la prevalencia del Papanicolau fue de 45.5% (aún no había cifra para la prueba de VPH).
Además, “se observó que las mujeres que viven con mayores vulnerabilidades, las más pobres, son las que menos usan las
pruebas de detección”, señala el equipo, encabezado por Leith León-Maldonado y Nancy López-Olmedo del Instituto Nacional de Salud Pública, que hizo la investigación para la ENSANUT más reciente. Añade que las mujeres que viven en zonas urbanas son las que más usan las pruebas de detección.
Epílogo de programa y recursos
Según el reporte de León-Maldonado y colaboradores, México tiene la capacidad para alcanzar la eliminación del cáncer cervical como problema de salud pública; pero requeriría de “un programa único” que “trazaría las directrices para las instituciones públicas y unificaría el uso de las pruebas de tamizaje, la comunicación de resultados y las estrategias de consejería”. Y, claro, agregan, “se requiere de soporte financiero permanente para operar el programa de forma eficiente e ininterrumpida en todas las entidades federativas”.
¡Lo que el viento se llevó!
MAR DE FONDO
Periodista con más de 35 años de carrera. Conocido por conducir espacios informativos en Radio y Televisión. Es presidente fundador de la Academia Nacional de Periodistas de Radio y Televisión A.C. Premio México de Periodismo Ricardo Flores Magón 2022. Enrique Lazcano

n la década de los 40 en Estados Unidos, causó furor un libro escrito por Margaret Mitchell. Una novela cuya trama sucedía en la guerra civil de la Unión Americana. Al poco tiempo, ese relato, fue llevado al cine con un extraordinario éxito. Sirva el título de esa trama, para referirme en una pretendida analogía, a lo que ha sucedido en la sociedad mexicana en las últimas décadas. En el ejercicio del recuerdo con el que inicié este escrito, rescato un par de episodios que sucedieron en aquel México cada día más lejano: A finales de 1942, un joven de 26 años, recién egresado de sus estudios como químico, era señalado por la policía capitalina como el autor material del asesinato de cuatro mujeres, cuyos cuerpos habría enterrado en el jardín trasero de su casa, ubicada en un viejo barrio de la capital. El carnicero de Tacuba, lo llamo el periodismo de aquellos años.
›En los inicios de los 60, la misma prensa daba a conocer la detención de las hermanas González Valenzuela, mejor conocidas como Las Poquianchis Estas mujeres se habían dedicado, al amparo de la justicia, a la trata de otras mujeres. También eran responsables del asesinato de jóvenes que se resistían a los abusos y ultrajes de estas hermanas.
A mediados de 1945, la radio y prensa mexicana llenaban sus espacios con información sobre el robo del niño Fernando Bohigas. Este pequeño había sido secuestrado a las puertas de su casa en la calle de Liverpool, en la colonia Juárez. Aquel México se estremeció con la historia del pequeño Fernando.
Al final, la trama tuvo un final feliz. La policía dio no con una banda de roba chicos, ni con un delincuente dedicado al secuestro. La responsable era una mujer, cuya maternidad le estaba negada por un desorden de salud. El caso del niño Bohigas, despertó tanto interés que el cineasta Ismael Rodríguez, decidió llevar la historia a la pantalla con el título de Ya tengo a mi hijo.
La idea de retrotraer a este tiempo aquellas tres historias no es otra que reflexionar sobre algunas cosas. Los datos que hemos recuperado en este articulo nos muestran un México en el que una sociedad completa podía indignarse, sorprenderse, y aún espantarse ante los actos cometidos por estos sujetos. En el México de hoy, más de medio siglo después, el negocio de trata de personas, el secuestro y el asesinato rebasan cualquier cantidad imaginable en aquellos días.
Entonces, cabe preguntarse, ¿qué fue lo que el viento se llevó? Yo espero que muchas cosas. Cosas que se pierden al paso de los años, pero confío que entre ellas no esté nuestra capacidad de asombro, de empatía, y sobre todo, nuestra capacidad de indignación.
: EN UN MUNDO MULTICONECTADO, el comercio y la diplomacia turcas en la región han aumentado notablemente, en una relación que refleja un interés del presidente Erdogan


BRENDA MIRELES blopez@ejecentral.com.mx
En los últimos años, un país de Medio Oriente ha estado aumentando sus representantes diplomáticos y comerciales en la región latinoamericana, y con ello, su presencia. Se trata de Turquía, que desde el inicio de la gestión del presidente Recep Tayyip Erdoğan en 2014, ha incrementado su presencia en la parte sur del continente americano, ya sea en Chile o en El Salvador.
Nuestro país no es ajeno a este boom. De acuerdo con información de DataMéxico y el Banco de México, la Participación de Turquía en las importaciones de México pasó del 0.21% en el año 2020 al 0.3% durante el 2023.
Aunque la cifra no es estratosférica, cabe destacar que, durante 2023, las importaciones de Turquía a México ascendieron a los 10 mil 800 millones de dólares estadounidenses; una cifra que ya marcaba una tendencia ascendente desde 2009, y que se interrumpió únicamente durante la pandemia de Covid en el 2020.
De manera específica, los estados de Zacatecas y Oaxaca fueron los más beneficiados del intercambio comercial con Turquía, al reportar cuatro mil millones 210 mil; cuatro mil millones y 70mil dólares, respectivamente, por concepto de mayores ventas internacionales con menos compras internacionales.
Junto al comercio, nuestro país también ha reportado un aumento lento
pero constante de migrantes turcos, la mayoría de los cuales llegan a Aguascalientes, Ciudad de México y Tabasco por motivos laborales y económicos, según datos del Instituto Nacional de Estadística y Geografía (Inegi).
Entre los comercios turcos que han llegado recientemente a suelo mexicano y se han expandido se encuentra Mata Automotive. La fabricante de componentes para automóviles de alta gama se instaló en Aguascalientes en marzo de este año, con una inversión de 30 millones de dólares, y generó 400 nuevos empleos directos.
La diplomacia turca también juega un papel importante entre ambas naciones. Las relaciones entre México y Turquía datan de 1928, y en 2013, el vínculo pasó de representar relaciones bilaterales al de una asociación estratégica gracias a la firma del “Marco de Cooperación Estratégica y Asociación México-Turquía para el Siglo XXI”.
Actualmente, entre ambos países existen 14 acuerdos bilaterales, que abarcan temas que van desde la cooperación educativa y cultural, hasta el trabajo conjunto contra el tráfico ilícito de estupefacientes y sustancias psicotrópicas.
La presencia de Turquía no se limita únicamente a México. Otros países de la región latinoamericana también siguen la misma tendencia.
Una prueba de ello está en El Salvador, donde a inicios de este mes se dio a conocer el desarrollo de un centro logístico de mercancías en Centroamérica, ubicado en este país.
Otro ejemplo se puede encontrar en Chile, donde la empresa Balsu Gida –dedicada al procesamiento y venta de avellanas–, anunció a inicios de año la construcción de una planta, la primera en el continente.
Se estima que, en toda la región latinoamericana, el comercio bilateral se multiplicó por 14, al pasar de 950 millones de dólares en 2002 a 13 mil 900 millones para el 2023, esto de acuerdo con datos del Ministerio de Asuntos Exteriores de Turquía.
Incluso a pocos meses de terminar este año, se ha calculado que, con corte a junio del 2024, el comercio creció 29.8% interanual.
De este monto, 62% fueron importaciones turcas, mientras que el 38% restante se compone de exportaciones, según el Instituto de Estadística Turco (TUIK).
Turquía cuenta con representantes en varios de los eventos organizados por las organizaciones que agrupan a las naciones latinas, tales como la Organización de los Estados Americanos (OEA) y la Comisión Económica para América Latina y el Caribe.
La mayoría de las empresas turcas pertenecen a los sectores automotriz, minero y de transporte. De ellas, una de las más destacadas es la de aviación: Turkish Airlines ya cuenta con vuelos directos a México, Brasil, Cuba, Colombia, Panamá y Venezuela, y planea inaugurar vuelos a Chile en diciembre de este año, mientras que, en nuestro país, se encuentra desarrollando actualmente el transporte de carga. Parte del interés de Turquía en la región perteneciente a Latinoamérica, de acuerdo con especialistas, se debe al interés de ambas partes en el comercio, pero cabe destacar que el presidente Recep Tayyip Erdoğan ha mostrado cierta cercanía con los países latinos.
El acuerdo, que fue firmado por el entonces presidente de la República de Turquía, Abdullah Gül, y el presidente de México, Enrique Peña Nieto, marcó el aumento de la cooperación y coordinación en organizaciones multilaterales, entre las que se encuentran la Organización de las Naciones Unidas (ONU) y la Organización para la Cooperación y el Desarrollo Económico (OCDE). Lee el artículo completo en nuestro sitio web


Archivo negro: sombras del crimen, hechos que marcaron la historia reciente de México
La elección de la tonalidad en tu recámara no sólo embellece, sino que mejora tu bienestar en un entorno relajante y personalizado
RUBÍ ENRÍQUEZ redaccion@ejecentral.com.mx
El color de tu recámara influye en tu bienestar, no sólo en términos estéticos, sino cómo afecta tu estado de ánimo y la calidad del sueño.
Un enfoque popular para elegir una paleta de colores es la regla del 60-3010. Este método sugiere que 60% del color dominante se aplique en paredes y muebles grandes, 30% en textiles y accesorios, y 10% en adornos.
Si deseas algo lleno de energía, una paleta de colores complementarios es una gran opción. Los colores opuestos en la rueda cromática, como el azul y el naranja, generan un contraste vibrante y equilibrado, al aportar dinamismo al ambiente.
Si prefieres un entorno relajante, los tonos neutros con acentos de color son ideales. Usar blanco, gris o beige como base, combinado con toques de color en decoraciones, puede lograr un espacio tranquilo sin que luzca monótono.
Probar el color en la pared es clave para ver cómo la iluminación lo afecta. Lo importante es que el espacio refleje tu personalidad e invite a relajarte.
¿SABÍAS QUE? Tonos como el azul y verde, conocidos por sus efectos calmantes, ayudan a reducir el estrés y crear un entorno ideal para el descanso.
Si no tienes algún color en mente para tu recámara, estas son algunas de las tendencias de colores para recámaras.
AZUL OCEÁNICO
Este tono está inspirado en las profundidades marinas, por lo que aporta una sensación de calma y tranquilidad.
TIERRA DE SIENA TOSTADA
Un color cálido y acogedor que evoca la esencia de la tierra, ideal para crear ambientes íntimos y confortables.
VERDE MENTA
Este color revitalizante es ideal para espacios donde se busca energía positiva y frescura.
LAVANDA SUAVE
Un tono pastel delicado que invita a la relajación y es perfecto para dormitorios.
AMARILLO
MOSTAZA
Audaz y vibrante que ilumina cualquier habitación y se convierte en el punto focal del espacio.
GRIS Y BEIGE
Tonos neutros que crean un ambiente sereno y relajante, ideales para promover la tranquilidad.
TERRACOTA Y ROSA PALO
Tonos tierra que añaden calidez y un toque acogedor a la decoración.
EL CONTEXTO LO ES TODO
Simón Sánchez @yonosoySaimon

Guionista y escritor con más de 20 años de experiencia, amante del cine y de las buenas series de televisión.
La nota roja es un género de prensa sensacionalista, también conocida como nota amarilla, que se enfoca exclusivamente en historias que involucran violencia física, principalmente ocasionada por robos, accidentes trágicos, asesinatos, ejecuciones y desastres naturales. Estas noticias suelen ser reproducidas en periódicos completos, secciones de estos, revistas y televisión, sin mencionar las diferentes redes sociales.
Este tipo de prensa está dirigido principalmente a las clases sociales más bajas. La nota roja combina narraciones sensacionalistas con imágenes sumamente gráficas en comparación con otros tipos de prensa; las fotografías que ilustran este tipo de notas muestran, sin pudor alguno, a las víctimas de delitos o accidentes, es decir, imágenes crudas sin respeto por la privacidad de estas personas. Los encabezados están escritos para captar la atención y buscan ser exagerados o melodramáticos, además de ser impresos de forma simple o con colores contrastantes. Una de las principales críticas que recibe la nota roja es que solamente muestra los puntos de vista de las autoridades, sin dar la oportunidad de entender el contexto social en el que suceden los crímenes, ni las herramientas necesarias para prevenirlos.
Es en este contexto de la nota roja donde la miniserie documental Archivo negro: sombras del crimen encuentra su principal fuente de información. Este trabajo retrata cinco casos policiacos que, en su momento, fueron la comidilla de medios amarillistas, dejando una profunda huella en la Ciudad de México y su zona conurbada. A través de un exhaustivo trabajo de investigación y utilizando un vasto material de archivo, además de la participación de algunos de los mismos asesinos que dan su testimonio a cámara, se construye este relato de verdadero terror, explorando las repercusiones oscuras, por decir lo menos, que estos sucesos tuvieron en la sociedad mexicana.
El primer capítulo, titulado La Jefa, narra el caso de El Coqueto, un feminicida serial que, en los límites de la Ciudad de México, asesinó y violó a un puñado de mujeres, y cómo Italy Ciani, conocida como La Jefa y en ese momento subprocuradora, encabezó un operativo para dar con el asesino.
El caso Serment, segundo capítulo de la serie, relata el homicidio de León Serment y su exesposa, Adriana Rosique, perpetrado por el hijo de ambos, Benjamín, con ayuda de su novia y un par de asesinos a sueldo.
El tercer capítulo, El silencio de Elvira, aborda el asesinato de cuatro hermanitos que conmocionó a la Ciudad de México. Elvira, madre de los niños, es acusada de matarlos a través de versiones algo confusas, mostrándonos un caso donde la injusticia es la principal protagonista. Robachicos es el cuarto capítulo, en el cual se utiliza el secuestro del niño Miguel Arizmendi en los años 80 para contar la verdadera pesadilla para los niños: la leyenda de El Robachicos
Por último, El asesino de la zona rosa, el quinto capítulo, narra el asesinato, bajo el mismo patrón, de cuatro miembros de la comunidad LGBT a manos de un asesino serial con pasado militar. Auténticos crímenes de odio. Archivo negro: sombras del crimen es un trabajo de excelente manufactura que entra en el género de documental negro. Cada episodio duele y, al mismo tiempo, invita a la reflexión a su manera. Está disponible en VIX.
› Descubre la combinación de historia colonial, arquitectura barroca y gastronomía a través de la Ruta del Vino, la majestuosa Peña de Bernal y el colorido Amealco
BY

: EXPLORA UN DESTINO
pletórico de historia y cultura mediante la arquitectura barroca, mientras disfrutas de los encantos naturales y de los monumentos
EDUARDO VELASQUILLO redaccion@ejecentral.com.mx
L¿SABÍAS QUE? La ubicación estratégica de Querétaro y su excelente infraestructura la han convertido en un punto clave para la inversión y el turismo de negocios.
os purépechas llamaban a esta región Queréndaro, que significa “lugar de piedras grandes”. Querétaro fue un importante punto de encuentro entre las culturas indígena y española, dando lugar a un mestizaje cultural que se refleja en su arquitectura, tradiciones y gastronomía. El estado también ha jugado un papel importante en el desarrollo histórico del país. Querétaro concentra la modernidad de una metrópoli vibrante con el pasado colonial de la capital y de las misiones, las bellezas naturales de la Sierra Gorda y Tequesquitengo, y una riqueza culinaria en su región de vinos y quesos. Y qué decir de su gastronomía, con platillos como la barbacoa, las enchiladas queretanas, las gorditas de maíz quebrado y los tamales de cacahuate.

Santiago de Querétaro
КSu centro histórico virreinal está tan bien conservado que recibió el título de Patrimonio Cultural de la Humanidad por la Unesco. En Querétaro hay mucho que ver, pero te mencionamos algunos lugares que no te puedes perder.

КEn este sitio se encuentra el tercer monolito más grande del mundo. Es visitado por los amantes de la escalada y el rappel. La Peña era un símbolo cósmico de ceremonias antiguas. El pueblo es colorido y su gastronomía, deliciosa. Las gorditas de maíz son las mejores exponentes de su cocina, pero el pan dulce, los helados y los esquites no les piden nada.

КEl templo y convento de San Agustín ubicado en el centro histórico, es uno de los monumentos más importantes del barroco. Fue fundado en 1745 por la orden de los agustinos. Su fachada es una obra maestra del barroco, con nichos decorados con santos agustinos y ornamentos que parecen brotar de las paredes. No te pierdas el claustro, considerado uno de los más bellos de la época virreinal. El conjunto actualmente alberga el Museo de Arte de Querétaro.

КEl Cerro de las Campanas tiene un valor histórico por ser el lugar en el que en 1867 el emperador Maximiliano fue fusilado. Actualmente es un parque nacional. En él se puede visitar la capilla que se levantó en honor del emperador, y el monumento a Benito Juárez.

se apareció en el cielo durante la batalla entre españoles e indígenas en 1531. Este acontecimiento marcó la fundación de la ciudad. La iglesia original, construida en el siglo XVI, fue el primer colegio para misioneros de América, desde donde partió fray Junípero Serra hacia California.
En 2023, Querétaro tuvo una derrama económica de 22 mil millones de pesos en el ámbito turístico.


Ruta del vino
КEs un destino turístico reconocido a nivel mundial, con más de 60 viñedos que ofrecen recorridos guiados y experiencias únicas. Los vinos queretanos han ganado numerosos premios internacionales, al consolidar a la región como uno de los principales productores de vino en México.
КLos orígenes del vino en Querétaro se remontan a la época colonial, cuando los españoles introdujeron la vid en la región a mediados del siglo XVI. Las condiciones climáticas y el suelo fértil del Valle de Querétaro fueron ideales para el cultivo de la uva.
КA partir de la década de 1970 del siglo XX, el surgimiento de nuevas bodegas alrededor de la ciudad de Tequisquiapan, que introdujeron técnicas modernas de producción y vinificación, impulsó la calidad de los vinos y los colocó en el mercado nacional e internacional.
КEl acueducto fue construido entre 1726 y 1738 para llevar agua a la ciudad. Es una construcción monumental de 74 arcos que alcanzan una altura promedio de 28.5 m y una longitud de mil 298 metros.


КEl templo de Santa Rosa de Viterbo es un tesoro arquitectónico y un ejemplo del barroco mexicano. Su construcción comenzó en 1727 y fue originalmente parte de un convento de monjas de clausura. Su fachada es fascinante. En el interior, los retablos dorados de estilo barroco asombran por su belleza.
КEn este Pueblo Mágico nació la muñeca “Lele”, catalogada como Patrimonio Cultural del estado. Amealco es una ciudad multicolor en la que las artesanías juegan un papel muy im portante. La parroquia de Santa María es considerada uno de los templos más bonitos y grandes de todo el estado, por sus pisos originales de madera y respiraderos de bronce. Su campana, a la que llaman Consagrada, se toca solo los domingos o en festividades religiosas.

>Un estudio de The Lancet advierte sobre un aumento alarmante en muertes por infecciones resistentes, proyectando hasta 208 millones de decesos en 25 años, especialmente entre personas mayores de 70 años
UNA SEÑAL DE ALARMA
К La resistencia a los antibióticos (RAM) podría provocar 208 millones de muertes en los próximos 25 años, y afectar principalmente a personas mayores de 70 años que son más vulnerables a infecciones graves.

К Un estudio de The Lancet estima que más de 39 millones de personas morirán directamente a causa de la RAM y 169 millones de forma indirecta, asociadas a otras patologías, lo que pone en riesgo los sistemas de salud globales.


En los países de ingresos altos, se proyecta un aumento del 72% en la mortalidad por RAM entre Mientras que en el norte de África y Oriente Próximo el incremento podría alcanzar un alarmante 72% 234%
Fotos: Freepik, Especial
La ONU ha clasificado la resistencia a los antibióticos como una de las amenazas existenciales más serias para la humanidad, resaltando la urgencia de adoptar medidas globales para evitar que esta crisis de salud pública cause millones de muertes en el futuro.
ALARMANTES Y TENDENCIAS
К Para 2050, se espera que las muertes anuales directas por RAM alcancen 1 91 millones, y si se incluyen las muertes indirectas, el total podría aumentar entre 4 71 millones y 8 22 millones, lo que representa un aumento del 75% en comparación con cifras actuales.
К Para enfrentar la crisis de la RAM, es crucial implementar nuevas vacunas y tratamientos que sean efectivos contra las infecciones graves, así como mejorar el acceso a antibióticos existentes, asegurando su uso adecuado y responsable.
К La inteligencia artificial está revolucionando el descubrimiento de nuevos antibióticos, acelerando el proceso de investigación y desarrollo, reduciendo lo que


К Desde 1990, ha habido una notable disminución del 50% en muertes por RAM en niños menores de cinco años, pasando de 488,000 a 193,000 muertes directas, gracias a mejoras en la atención médica, vacunación y control de infecciones.
К A pesar de esta reducción en los niños, la resistencia antimicrobiana sigue siendo una de las diez principales amenazas para la salud global, según la Organización Mundial de la Salud (OMS), subrayando la necesidad de acción inmediata.

